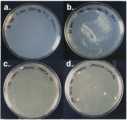

KR20230102695A - Vegetable albumin and method for preparing same - Google Patents
Vegetable albumin and method for preparing sameDownload PDFInfo
- Publication number
- KR20230102695A KR20230102695AKR1020210193031AKR20210193031AKR20230102695AKR 20230102695 AKR20230102695 AKR 20230102695AKR 1020210193031 AKR1020210193031 AKR 1020210193031AKR 20210193031 AKR20210193031 AKR 20210193031AKR 20230102695 AKR20230102695 AKR 20230102695A
- Authority
- KR
- South Korea
- Prior art keywords
- seq
- albumin
- nucleic acid
- leu
- lys
- Prior art date
- Legal status (The legal status is an assumption and is not a legal conclusion. Google has not performed a legal analysis and makes no representation as to the accuracy of the status listed.)
- Ceased
Links
Images
Classifications
- C—CHEMISTRY; METALLURGY
- C07—ORGANIC CHEMISTRY
- C07K—PEPTIDES
- C07K14/00—Peptides having more than 20 amino acids; Gastrins; Somatostatins; Melanotropins; Derivatives thereof
- C07K14/435—Peptides having more than 20 amino acids; Gastrins; Somatostatins; Melanotropins; Derivatives thereof from animals; from humans
- C07K14/76—Albumins
- A—HUMAN NECESSITIES
- A23—FOODS OR FOODSTUFFS; TREATMENT THEREOF, NOT COVERED BY OTHER CLASSES
- A23L—FOODS, FOODSTUFFS OR NON-ALCOHOLIC BEVERAGES, NOT OTHERWISE PROVIDED FOR; PREPARATION OR TREATMENT THEREOF
- A23L29/00—Foods or foodstuffs containing additives; Preparation or treatment thereof
- A23L29/20—Foods or foodstuffs containing additives; Preparation or treatment thereof containing gelling or thickening agents
- A23L29/275—Foods or foodstuffs containing additives; Preparation or treatment thereof containing gelling or thickening agents of animal origin, e.g. chitin
- A23L29/281—Proteins, e.g. gelatin or collagen
- A—HUMAN NECESSITIES
- A61—MEDICAL OR VETERINARY SCIENCE; HYGIENE
- A61K—PREPARATIONS FOR MEDICAL, DENTAL OR TOILETRY PURPOSES
- A61K38/00—Medicinal preparations containing peptides
- A61K38/16—Peptides having more than 20 amino acids; Gastrins; Somatostatins; Melanotropins; Derivatives thereof
- A61K38/17—Peptides having more than 20 amino acids; Gastrins; Somatostatins; Melanotropins; Derivatives thereof from animals; from humans
- A61K38/38—Albumins
- A—HUMAN NECESSITIES
- A61—MEDICAL OR VETERINARY SCIENCE; HYGIENE
- A61K—PREPARATIONS FOR MEDICAL, DENTAL OR TOILETRY PURPOSES
- A61K8/00—Cosmetics or similar toiletry preparations
- A61K8/18—Cosmetics or similar toiletry preparations characterised by the composition
- A61K8/30—Cosmetics or similar toiletry preparations characterised by the composition containing organic compounds
- A61K8/64—Proteins; Peptides; Derivatives or degradation products thereof
- C—CHEMISTRY; METALLURGY
- C12—BIOCHEMISTRY; BEER; SPIRITS; WINE; VINEGAR; MICROBIOLOGY; ENZYMOLOGY; MUTATION OR GENETIC ENGINEERING
- C12N—MICROORGANISMS OR ENZYMES; COMPOSITIONS THEREOF; PROPAGATING, PRESERVING, OR MAINTAINING MICROORGANISMS; MUTATION OR GENETIC ENGINEERING; CULTURE MEDIA
- C12N15/00—Mutation or genetic engineering; DNA or RNA concerning genetic engineering, vectors, e.g. plasmids, or their isolation, preparation or purification; Use of hosts therefor
- C12N15/09—Recombinant DNA-technology
- C12N15/63—Introduction of foreign genetic material using vectors; Vectors; Use of hosts therefor; Regulation of expression
Landscapes
- Health & Medical Sciences (AREA)
- Life Sciences & Earth Sciences (AREA)
- Chemical & Material Sciences (AREA)
- Genetics & Genomics (AREA)
- Engineering & Computer Science (AREA)
- Zoology (AREA)
- Organic Chemistry (AREA)
- General Health & Medical Sciences (AREA)
- Bioinformatics & Cheminformatics (AREA)
- Biochemistry (AREA)
- Proteomics, Peptides & Aminoacids (AREA)
- Veterinary Medicine (AREA)
- Public Health (AREA)
- Wood Science & Technology (AREA)
- Medicinal Chemistry (AREA)
- General Engineering & Computer Science (AREA)
- Biomedical Technology (AREA)
- Biotechnology (AREA)
- Animal Behavior & Ethology (AREA)
- Biophysics (AREA)
- Epidemiology (AREA)
- Molecular Biology (AREA)
- Gastroenterology & Hepatology (AREA)
- Birds (AREA)
- Physics & Mathematics (AREA)
- Toxicology (AREA)
- Pharmacology & Pharmacy (AREA)
- Plant Pathology (AREA)
- Microbiology (AREA)
- Immunology (AREA)
- Dispersion Chemistry (AREA)
- Nutrition Science (AREA)
- Food Science & Technology (AREA)
- Polymers & Plastics (AREA)
- Preparation Of Compounds By Using Micro-Organisms (AREA)
- Micro-Organisms Or Cultivation Processes Thereof (AREA)
Abstract
Translated fromKoreanDescription
Translated fromKorean본 발명은 식물성 알부민 및 이의 제조 방법에 관한 것이다.The present invention relates to vegetable albumin and methods for its preparation.
인류의 발전과 인구 증가에 따라 육류의 소비는 증가하고 있다. 국제연합식량농업기구(Food and Agriculture Organization of the United Nations: FAO)에 의하면 2050년 세계인구는 약 93억명으로 계속해서 증가할 것으로 예상됨에 따라 미래 육류 수요는 연간 465만톤으로 예상되며 생산량이 매년 2억톤씩 증가해야 수요량을 맞출 수 있을 것으로 전망된다. 육류 수요를 만족하기 위하여 공장식 사육이 증가하고 있는데, 이러한 경우 동물의 이산화탄소 배출, 분뇨에 의한 환경 오염, 비인간적 사육 및 도축에 의한 동물복지 등의 문제가 야기된다.BACKGROUND OF THE INVENTION With human development and population growth, meat consumption is increasing. According to the Food and Agriculture Organization of the United Nations (FAO), the world population in 2050 is expected to continue to increase to about 9.3 billion, so the future meat demand is expected to be 4.65 million tons per year, and the production is expected to be 2 per year. It is expected that the demand will be met only if it increases by 100 million tonnes. In order to satisfy the demand for meat, factory breeding is increasing. In this case, problems such as carbon dioxide emission of animals, environmental pollution due to manure, and animal welfare due to inhumane breeding and slaughtering are caused.
한편, 웰빙(well-being) 트렌드에 맞추어 저지방 또는 저칼로리 식품, 플렉시블 베지테리언(Flexible Vegeterian), 일명 플렉시테리언(flexi-tarian) 등이 등장하였으며 채식주의자가 증가하는 추세이므로, 동물성 육류를 영양학적으로 대체할 수 있는 식물성 대체육에 대한 소비자들의 관심이 증가하고 있다. 이에, 계란 대체 식품 개발 또한 콩, 두부, 생선, 소고기, 유부 등을 활용하여 경쟁적으로 진행되고 있다.On the other hand, in line with the well-being trend, low-fat or low-calorie foods, flexible vegetarians, so-called flexi-tarians, etc. have appeared, and vegetarians are on the rise, so animal meat is considered nutritious. Consumer interest in vegetable substitute meat that can be replaced with meat is increasing. Accordingly, egg substitute food development is also proceeding competitively by utilizing soybeans, tofu, fish, beef, tofu, and the like.
본 발명의 목적은 알부민을 암호화하는 핵산을 제공하는 데에 있다.It is an object of the present invention to provide nucleic acids encoding albumin.
본 발명의 또 다른 목적은 상기 알부민 발현 카세트, 상기 발현 카세트를 포함하는 발현 벡터 또는 상기 벡터로 형질전환된 형질전환체를 제공하는 데에 있다.Another object of the present invention is to provide the albumin expression cassette, an expression vector containing the expression cassette, or a transformant transformed with the vector.
본 발명의 또 다른 목적은 상기 형질전환체의 배양물을 제공하는 데에 있다.Another object of the present invention is to provide a culture of the transformant.
본 발명의 또 다른 목적은 상기 형질전환체의 배양물로부터 알부민을 생산하는 방법을 제공하는 데에 있다.Another object of the present invention is to provide a method for producing albumin from the culture of the transformant.
본 발명의 또 다른 목적은 상기 배양액을 포함하는 식품 조성물, 화장품 조성물 또는 약학 조성물을 제공하는 데에 있다.Another object of the present invention is to provide a food composition, cosmetic composition or pharmaceutical composition containing the culture medium.
상기 목적을 달성하기 위하여, 본 발명은 서열번호 1 내지 8로 이루어진 군에서 선택된 하나 이상의 아미노산 서열을 포함하는 알부민을 암호화하는 핵산을 제공한다.In order to achieve the above object, the present invention provides a nucleic acid encoding albumin comprising one or more amino acid sequences selected from the group consisting of SEQ ID NOs: 1 to 8.
또한, 본 발명은 서열번호 1 내지 8로 이루어진 군에서 선택된 하나 이상의 아미노산 서열을 포함하는 알부민 발현 카세트를 제공한다.In addition, the present invention provides an albumin expression cassette comprising one or more amino acid sequences selected from the group consisting of SEQ ID NOs: 1 to 8.
또한, 본 발명은 상기 알부민 발현 카세트를 포함하는 발현 벡터를 제공한다.In addition, the present invention provides an expression vector comprising the albumin expression cassette.
또한, 본 발명은 상기 발현 벡터로 형질전환된 형질전환체를 제공한다.In addition, the present invention provides a transformant transformed with the expression vector.
또한, 본 발명은 상기 형질전환체를 배양하여 수득한 배양물을 제공한다.In addition, the present invention provides a culture obtained by culturing the transformant.
또한, 본 발명은 형질전환체를 배양하는 단계를 포함하는 알부민 생산 방법을 제공한다.In addition, the present invention provides an albumin production method comprising culturing the transformant.
또한, 본 발명은 상기 배양물을 포함하는 약학 조성물을 제공한다.In addition, the present invention provides a pharmaceutical composition comprising the culture.
또한, 본 발명은 상기 배양물을 포함하는 식품 조성물을 제공한다.In addition, the present invention provides a food composition comprising the culture.
또한, 본 발명은 상기 배양물을 포함하는 화장품 조성물을 제공한다.In addition, the present invention provides a cosmetic composition comprising the culture.
본 발명은 식물성 알부민 유전자 및 이의 제조 방법에 관한 것으로, 상기 유전자 발현 카세트, 벡터 및 형질전환체를 이용한 경우, 알부민을 대량 생산할 수 있을 뿐만 아니라 동물성 원료를 사용하지 않고도 알부민을 생산하거나 계란 흰자를 대체하는데 활용할 수 있다.The present invention relates to a plant albumin gene and a method for producing the same, and when the gene expression cassette, vector, and transformant are used, albumin can be mass-produced, and albumin can be produced without using animal raw materials or egg white replacement. can be used to do
도 1은 a) pPICZaA, b) pPICZaA-ALB, c) pESC-URA, d) pESC-URA-ALB 벡터 구조를 나타낸 것이다.
도 2a는Pichia pastoris에서 Glycine Max의 알부민 코돈 최적화된(codon optimized) 서열을 포함하는 알부민 발현 플라스미드와Pichia pastoris 형질전환체의 구조를 나타낸 것이다. 도 2b는 프로모터, 시그널 펩타이드, 알부민 유전자, 종결 서열 및 마커를 포함하는 카세트 구조를 나타낸 것이다.
도 3a는 알부민 발현 벡터로 형질전환된 알부민 생산 균주의 콜로니를 나타낸 것이다. a는 알부민 생성 플라스미드가 없는S.cerevisiae대조군의 플레이트; b는 알부민 생산 플라스미드(pESC-URA-ALB)를 갖는 S. cerevisiae 균주의 플레이트 및 콜로니; c는 알부민 생성 플라스미드가 없는P. pastoris대조군의 플레이트; d는 알부민 생성 플라스미드(pPICZaA-ALB)를 갖는P. pastoris균주의 플레이트 및 콜로니를 나타낸 것이다. 도 3b는 이의 배양액 및 폴리아크릴아마이드 겔 전기 영동법(sodium dodecyl sulphate-polyacrylamide gel electrophoresis: SDS-PAGE)으로 산물을 확인한 결과이다.
도 4는 알부민 발현 벡터로 형질전환된 알부민 생산 균주의 배양액과 대조군 균주의 배양액에서 버블 생성 정도를 나타낸 것이다.
도 5는 알부민 발현 벡터로 형질전환된 알부민 생산 균주의 배양액과 대조군 균주의 배양액에서 상등액을 취한 후 버블 생성 정도를 나타낸 것이다.
도 6은 알부민 발현 벡터로 형질전환된 알부민 생산 균주와 대조군 균주를 배양한 배양액에서 생산된 단백질의 농도를 측정한 것이다.
도 7은 알부민 생산 균주 배양액과 계란 흰자의 버블 생성 정도를 비교한 것이다.
도 8은 계란 흰자, 알부민 생산 균주의 배양 배지 및 대조군 생산 균주의 배양 배지를 이용하여 머랭을 만들고 완성도를 비교한 것이다. 왼쪽은 계란 흰자, 가운데는 알부민 생산 균주의 배양 배지, 오른쪽은 대조군 생산 균주 배양 배지의 상층액(동일한 양)을 이용하여 머랭을 만든 것이다.
도 9는 알부민 생산 균주의 배양 배지와 계란 흰자를 이용하여 머랭 쿠키를 만들고 완성도를 비교한 것이다. 왼쪽은 계란 흰자, 가운데는 알부민 생산 균주의 배양 배지, 오른쪽은 대조군 균주 배양액의 상층액(동일한 양)을 이용하여 머랭 쿠키를 만든 것이다.Figure 1 shows the structure of a) pPICZaA, b) pPICZaA-ALB, c) pESC-URA, and d) pESC-URA-ALB.
Figure 2a shows the structure of an albumin expression plasmid containing an albumin codon optimized sequence of Glycine Max inPichia pastoris anda Pichia pastoris transformant. Figure 2b shows the structure of the cassette including the promoter, signal peptide, albumin gene, termination sequence and marker.
Figure 3a shows colonies of albumin-producing strains transformed with albumin expression vectors. a isS.cerevisiae without the albumin-producing plasmidcontrol plate; b, plates and colonies ofS. cerevisiae strains with an albumin production plasmid (pESC-URA-ALB); c plate ofP. pastoris control without albumin producing plasmid; d shows plates and colonies ofP. pastoris strains carrying the albumin producing plasmid (pPICZaA-ALB). Figure 3b is the result of confirming the product by the culture solution and polyacrylamide gel electrophoresis (sodium dodecyl sulphate-polyacrylamide gel electrophoresis: SDS-PAGE).
Figure 4 shows the degree of bubble formation in the culture medium of the albumin-producing strain transformed with the albumin expression vector and the culture medium of the control strain.
Figure 5 shows the degree of bubble formation after taking the supernatant from the culture medium of the albumin-producing strain transformed with the albumin expression vector and the culture medium of the control strain.
6 is a measurement of the concentration of protein produced in the culture medium in which the albumin-producing strain transformed with the albumin expression vector and the control strain were cultured.
Figure 7 compares the degree of bubble formation between the albumin-producing strain culture medium and egg white.
8 is a comparison of the degree of completeness of meringues made using the culture medium of the egg white and albumin-producing strain and the culture medium of the control strain. On the left, meringue was made using egg white, the culture medium of the albumin-producing strain in the middle, and the supernatant (equal amount) of the culture medium of the control-producing strain on the right.
9 is a comparison of the perfection of meringue cookies made using the culture medium of the albumin-producing strain and egg whites. On the left, meringue cookies were made using egg white, the culture medium of the albumin-producing strain in the middle, and the supernatant (equal amount) of the culture medium of the control strain on the right.
이하, 본 발명을 보다 상세하게 설명한다.Hereinafter, the present invention will be described in more detail.
본 발명의 발명자들은 계란 흰자를 대체할 수 있는 단백질 생산을 위하여, 콩과 식물로부터 알부민 유전자 서열을 스크리닝, 선별 및 최적의 코돈을 설계하고, 발현 벡터를 제작하였다. 미생물을 이 발현 벡터로 형질전환하여 알부민 생산 재조합 미생물을 제작하였고, 이를 배양한 결과 알부민 단백질을 함유하는 배양액을 수득할 수 있었다. 수득한 배양액을 계란 흰자 대신 사용하여 식품, 예를 들면 머랭과 쿠키를 제조함으로써 계란 흰자를 대체할 수 있음을 확인하였다.The inventors of the present invention screened albumin gene sequences from leguminous plants, designed optimal codons, and constructed expression vectors in order to produce proteins that can replace egg whites. A microorganism was transformed with this expression vector to prepare an albumin-producing recombinant microorganism, and as a result of culturing the microorganism, a culture medium containing an albumin protein was obtained. It was confirmed that egg whites can be substituted by using the obtained culture medium instead of egg whites to prepare food, for example, meringue and cookies.
본 발명은 서열번호 1 내지 8로 이루어진 군에서 선택된 하나 이상의 아미노산 서열을 포함하는 알부민을 암호화하는 핵산을 제공한다.The present invention provides a nucleic acid encoding albumin comprising at least one amino acid sequence selected from the group consisting of SEQ ID NOs: 1 to 8.
상기 알부민(albumin)은 수용성 단백질을 말하며, 계란 흰자, 혈청 등에 존재하는 것으로 알려져 있다.The albumin refers to a water-soluble protein, and is known to exist in egg whites, serum, and the like.
본 발명에서 알부민은 무동물성(Animal-Free)으로 식물에서 유래한 알부민 단백질로 상기 식물은 콩과 식물일 수 있고, 대두(soy bean), 잠두(누에콩)(fava bean), 녹두(mug bean), 병아리콩(chick pea) 등일 수 있으나, 이에 제한되는 것은 아니다.In the present invention, albumin is an animal-free albumin protein derived from plants, and the plant may be legumes, such as soy bean, fava bean, and mung bean. , chick peas, etc., but is not limited thereto.
본 발명에 있어서, "핵산"은 DNA(gDNA 및 cDNA), RNA 등을 포괄적으로 포함하는 의미를 가지며, 폴리뉴클레오티드로 지칭될 수 있고, 핵산에서 기본 구성단위인 뉴클레오티드는 자연의 뉴클레오티드 뿐만 아니라, 당 또는 염기 부위가 변형된 유사체(analogue)도 포함한다. 상기 알부민을 암호화하는 핵산 서열은 변형될 수 있으며, 상기 변형은 뉴클레오티드의 추가, 결실, 비보존적 치환 또는 보존적 치환을 포함할 수 있다.In the present invention, "nucleic acid" has a meaning comprehensively including DNA (gDNA and cDNA), RNA, etc., and can be referred to as a polynucleotide, and nucleotides, which are basic structural units in nucleic acids, are not only natural nucleotides, but also sugars. or an analog in which the base site is modified. The nucleic acid sequence encoding the albumin may be modified, and the modification may include additions, deletions, non-conservative substitutions or conservative substitutions of nucleotides.
상기 알부민은 서열번호 1의 아미노산 서열, 서열번호 2의 아미노산 서열, 서열번호 3의 아미노산 서열, 서열번호 4의 아미노산 서열, 서열번호 5의 아미노산 서열, 서열번호 6의 아미노산 서열, 서열번호 7의 아미노산 서열 및 서열번호 8의 아미노산 서열로 이루어진 군에서 선택된 하나 이상을 포함하는 것일 수 있다.The albumin is the amino acid sequence of SEQ ID NO: 1, the amino acid sequence of SEQ ID NO: 2, the amino acid sequence of SEQ ID NO: 3, the amino acid sequence of SEQ ID NO: 4, the amino acid sequence of SEQ ID NO: 5, the amino acid sequence of SEQ ID NO: 6, the amino acid sequence of SEQ ID NO: 7 It may include one or more selected from the group consisting of the sequence and the amino acid sequence of SEQ ID NO: 8.
상기 서열번호 1의 아미노산 서열을 포함하는 단백질을 암호화하는 핵산은 서열번호 9 또는 서열번호 17의 염기 서열과 95% 이상의 서열 동일성을 갖는 핵산일 수 있고, 상기 서열번호 2의 아미노산 서열을 포함하는 단백질을 암호화하는 핵산은 서열번호 10 또는 서열번호 18의 염기 서열과 95% 이상의 서열 동일성을 갖는 핵산일 수 있고, 상기 서열번호 3의 아미노산 서열을 포함하는 단백질을 암호화하는 핵산은 서열번호 11 또는 서열번호 19의 염기 서열과 95% 이상의 서열 동일성을 갖는 핵산일 수 있다. 상기 서열번호 4의 아미노산 서열을 포함하는 단백질을 암호화하는 핵산은 서열번호 12 또는 서열번호 20의 염기 서열과 95% 이상의 서열 동일성을 갖는 핵산일 수 있고, 상기 서열번호 5의 아미노산 서열을 포함하는 단백질을 암호화하는 핵산은 서열번호 13 또는 서열번호 21의 염기 서열과 95% 이상의 서열 동일성을 갖는 핵산일 수 있고, 상기 서열번호 6의 아미노산 서열을 포함하는 단백질을 암호화하는 핵산은 서열번호 14 또는 서열번호 22의 염기 서열과 95% 이상의 서열 동일성을 갖는 핵산일 수 있다. 상기 서열번호 7의 아미노산 서열을 포함하는 단백질을 암호화하는 핵산은 서열번호 15 또는 서열번호 23의 염기 서열과 95% 이상의 서열 동일성을 갖는 핵산일 수 있고, 상기 서열번호 8의 아미노산 서열을 포함하는 단백질을 암호화하는 핵산은 서열번호 16 또는 서열번호 24의 염기 서열과 95% 이상의 서열 동일성을 갖는 핵산일 수 있다.The nucleic acid encoding the protein comprising the amino acid sequence of SEQ ID NO: 1 may be a nucleic acid having 95% or more sequence identity with the nucleotide sequence of SEQ ID NO: 9 or SEQ ID NO: 17, and the protein comprising the amino acid sequence of SEQ ID NO: 2 The nucleic acid encoding may be a nucleic acid having 95% or more sequence identity with the nucleotide sequence of SEQ ID NO: 10 or SEQ ID NO: 18, and the nucleic acid encoding a protein comprising the amino acid sequence of SEQ ID NO: 3 may be SEQ ID NO: 11 or SEQ ID NO: 11. It may be a nucleic acid having 95% or more sequence identity with the nucleotide sequence of 19. The nucleic acid encoding the protein comprising the amino acid sequence of SEQ ID NO: 4 may be a nucleic acid having 95% or more sequence identity with the nucleotide sequence of SEQ ID NO: 12 or SEQ ID NO: 20, and the protein comprising the amino acid sequence of SEQ ID NO: 5 The nucleic acid encoding may be a nucleic acid having 95% or more sequence identity with the base sequence of SEQ ID NO: 13 or SEQ ID NO: 21, and the nucleic acid encoding a protein comprising the amino acid sequence of SEQ ID NO: 6 may be SEQ ID NO: 14 or SEQ ID NO: 21. It may be a nucleic acid having 95% or more sequence identity with the nucleotide sequence of 22. The nucleic acid encoding the protein comprising the amino acid sequence of SEQ ID NO: 7 may be a nucleic acid having 95% or more sequence identity with the nucleotide sequence of SEQ ID NO: 15 or SEQ ID NO: 23, and the protein comprising the amino acid sequence of SEQ ID NO: 8 The nucleic acid encoding may be a nucleic acid having 95% or more sequence identity with the nucleotide sequence of SEQ ID NO: 16 or SEQ ID NO: 24.
상기 핵산은 그 서열과 실질적으로 동일하거나 상보적인 서열을 포함할 수 있다.The nucleic acid may include a sequence that is substantially identical to or complementary to that sequence.
상기 서열번호 1의 아미노산 서열을 포함하는 단백질을 암호화하는 핵산은 서열번호 9 또는 서열번호 17의 염기 서열을 포함하는 핵산일 수 있고, 상기 서열번호 2의 아미노산 서열을 포함하는 단백질을 암호화하는 핵산은 서열번호 10 또는 서열번호 18의 염기 서열을 포함하는 핵산일 수 있고, 상기 서열번호 3의 아미노산 서열을 포함하는 단백질을 암호화하는 핵산은 서열번호 11 또는 서열번호 19의 염기 서열을 포함하는 핵산일 수 있다. 상기 서열번호 4의 아미노산 서열을 포함하는 단백질을 암호화하는 핵산은 서열번호 12 또는 서열번호 20의 염기 서열을 포함하는 핵산일 수 있고, 상기 서열번호 5의 아미노산 서열을 포함하는 단백질을 암호화하는 핵산은 서열번호 13 또는 서열번호 21의 염기 서열을 포함하는 핵산일 수 있고, 상기 서열번호 6의 아미노산 서열을 포함하는 단백질을 암호화하는 핵산은 서열번호 14 또는 서열번호 22의 염기 서열을 포함하는 핵산일 수 있다. 상기 서열번호 7의 아미노산 서열을 포함하는 단백질을 암호화하는 핵산은 서열번호 15 또는 서열번호 23의 염기 서열을 포함하는 핵산일 수 있고, 상기 서열번호 8의 아미노산 서열을 포함하는 단백질을 암호화하는 핵산은 서열번호 16 또는 서열번호 24의 염기 서열을 포함하는 핵산일 수 있다.The nucleic acid encoding the protein comprising the amino acid sequence of SEQ ID NO: 1 may be a nucleic acid comprising the nucleotide sequence of SEQ ID NO: 9 or SEQ ID NO: 17, and the nucleic acid encoding the protein comprising the amino acid sequence of SEQ ID NO: 2 It may be a nucleic acid comprising the nucleotide sequence of SEQ ID NO: 10 or SEQ ID NO: 18, and the nucleic acid encoding a protein comprising the amino acid sequence of SEQ ID NO: 3 may be a nucleic acid comprising the nucleotide sequence of SEQ ID NO: 11 or SEQ ID NO: 19 there is. The nucleic acid encoding the protein comprising the amino acid sequence of SEQ ID NO: 4 may be a nucleic acid comprising the nucleotide sequence of SEQ ID NO: 12 or SEQ ID NO: 20, and the nucleic acid encoding the protein comprising the amino acid sequence of SEQ ID NO: 5 It may be a nucleic acid comprising the nucleotide sequence of SEQ ID NO: 13 or SEQ ID NO: 21, and the nucleic acid encoding a protein comprising the amino acid sequence of SEQ ID NO: 6 may be a nucleic acid comprising the nucleotide sequence of SEQ ID NO: 14 or SEQ ID NO: 22 there is. The nucleic acid encoding the protein comprising the amino acid sequence of SEQ ID NO: 7 may be a nucleic acid comprising the nucleotide sequence of SEQ ID NO: 15 or SEQ ID NO: 23, and the nucleic acid encoding the protein comprising the amino acid sequence of SEQ ID NO: 8 It may be a nucleic acid comprising the nucleotide sequence of SEQ ID NO: 16 or SEQ ID NO: 24.
본 발명에서, "서열 동일성(sequence identity)"은 특정 비교 영역에서 양 서열을 최대한 일치되도록 얼라인시킨 후 서열간의 염기의 동일한 정도를 의미한다. 서열 동일성은 특정 비교 영역에서 2개의 서열을 최적으로 얼라인하여 비교함으로써 측정되는 값으로서, 비교 영역 내에서 서열의 일부는 대조 서열(reference sequence)과 비교하여 부가 또는 삭제되어 있을 수 있다. 서열 동일성 백분율은 예를 들면, 비교 영역 전체에서 두 개의 최적으로 정렬된 서열을 비교하는 단계, 두 서열 모두에서 동일한 핵산이 나타나는 위치의 갯수를 결정하여 일치된(matched) 위치의 갯수를 수득하는 단계, 상기 일치된 위치의 갯수를 비교 범위 내의 위치의 총 갯수(즉, 범위 크기)로 나누는 단계, 및 상기 결과에 100을 곱하여 서열 동일성의 백분율을 수득하는 단계에 의해 계산될 수 있다. 상기 서열 동일성의 퍼센트는 공지의 서열 비교 프로그램을 사용하여 결정될 수 있으며, 상기 프로그램의 일례로 BLASTN (NCBI), CLC Main Workbench (CLC bio), MegAlignTM (DNASTAR Inc) 등을 들 수 있다.In the present invention, "sequence identity" means the degree of identicality of bases between sequences after aligning both sequences to maximize matching in a specific comparison region. Sequence identity is a value measured by optimally aligning and comparing two sequences in a specific comparison region, and a part of the sequence in the comparison region may be added or deleted compared to a reference sequence. Percentage sequence identity can be measured, for example, by comparing two optimally aligned sequences across the comparison region, determining the number of positions in which identical nucleic acids occur in both sequences, and obtaining the number of matched positions. , can be calculated by dividing the number of matched positions by the total number of positions within the comparison range (ie range size), and multiplying the result by 100 to obtain the percentage of sequence identity. The percent of sequence identity can be determined using a known sequence comparison program, examples of which include BLASTN (NCBI), CLC Main Workbench (CLC bio), MegAlign™ (DNASTAR Inc), and the like.
여러 종의 동일하거나 유사한 기능이나 활성을 가지는 핵산을 확인하는데 있어서 여러 수준의 서열 동일성을 사용할 수 있다. 예를 들어, 50% 이상, 55% 이상, 60% 이상, 65% 이상, 70% 이상, 75% 이상, 80% 이상, 85% 이상, 90% 이상, 95% 이상, 96% 이상, 97% 이상, 98% 이상, 99% 이상 또는 100% 일 수 있다.Different levels of sequence identity can be used to identify nucleic acids having the same or similar function or activity in different species. For example, 50% or more, 55% or more, 60% or more, 65% or more, 70% or more, 75% or more, 80% or more, 85% or more, 90% or more, 95% or more, 96% or more, 97% It may be greater than, 98%, 99%, or 100%.
서열번호 1 내지 8의 아미노산 서열 및 서열번호 9 내지 24의 염기 서열은 표 1, 3 및 4에 기재하였다.The amino acid sequences of SEQ ID NOs: 1 to 8 and the nucleotide sequences of SEQ ID NOs: 9 to 24 are shown in Tables 1, 3 and 4.
또한 본 발명은 상기 알부민 발현 카세트를 제공한다.In addition, the present invention provides the albumin expression cassette.
본 발명에서 "발현 카세트"는 프로모터, 핵산 및 전사 터미네이터 등을 포함하는 물질이다. 상기 발현 카세트는 프로모터, 알부민을 암호화하는 핵산 및 전사 터미네이터 등을 포함할 수 있다.In the present invention, an "expression cassette" is a substance including a promoter, nucleic acid, and transcription terminator. The expression cassette may include a promoter, a nucleic acid encoding albumin, and a transcription terminator.
또한 본 발명은 상기 알부민 발현 카세트를 포함하는 발현 벡터를 제공한다.In addition, the present invention provides an expression vector containing the albumin expression cassette.
본 발명에 있어서, "벡터"는 단리된 핵산을 포함하고 단리된 핵산을 운반하고 숙주 내에서 삽입된 핵산을 발현하기 위해 사용될 수 있는 스스로 복제되는 물질이다.In the present invention, a "vector" is a self-replicating material that contains an isolated nucleic acid and can be used to transport the isolated nucleic acid and to express the inserted nucleic acid in a host.
상기 발현 카세트 또는 벡터에 있어서, 상기 핵산은 조절 서열과 작동가능하게 연결될 수 있다. 상기 카세트는 조절 서열과 작동가능하게 연결된 단백질이 발현될 수 있는 단위 서열일 수 있다. 용어 "작동가능하게 연결된"은 핵산 발현 조절 서열과 다른 핵산 서열 사이의 기능적인 결합을 의미할 수 있다. 이로 인해, 상기 조절 서열은 상기 알부민을 암호화하는 핵산 서열의 전사 및/또는 번역을 조절할 수 있다. 상기 조절 서열은 복제 개시점, 프로모터, 터미네이터, 및/또는 인핸서를 포함할 수 있다. 상기 복제 개시점은 효모 자가복제 서열(autonomous replication sequence: ARS)을 포함할 수 있다. 상기 효모 자가복제서열은 효모 동원체 서열(centrometric sequence: CEN)에 의해 안정화될 수 있다. 상기 프로모터는 또한 알부민을 암호화하는 핵산과 작동적으로 결합할 수 있다. 상기 프로모터는 Covalently linked Cell Wall protein 12(CCW12), glyceraldehyde-3-phosphate dehydrogenase(GPD), Pyruvate DeCarboxylase 1(PDC1), phosphoglycerate kinase (PGK), Transcription enhancer factor 1(TEF1), glyceraldehyde-3-phosphate dehydrogenase(TDH), triose phosphate isomerase(TPI), purine-cytosine permease(PCPL3), GAL1, GAL10, CMV, EM7 및 alcohol dehydrogenase(ADH) 유전자 유래의 프로모터로 이루어진 군으로부터 선택될 수 있으나, 이제 제한되는 것은 아니다. 상기 터미네이터는 PGK1(phosphoglycerate kinase 1), CYC1(cytochrome c transcription) 및 GAL1로 이루어진 군으로부터 선택될 수 있으나, 이제 제한되는 것은 아니다.In the expression cassette or vector, the nucleic acid may be operably linked with regulatory sequences. The cassette may be a unit sequence capable of expressing a protein operably linked to regulatory sequences. The term “operably linked” can refer to a functional linkage between a nucleic acid expression control sequence and another nucleic acid sequence. As such, the regulatory sequence may regulate the transcription and/or translation of the nucleic acid sequence encoding the albumin. The regulatory sequences may include origins of replication, promoters, terminators, and/or enhancers. The origin of replication may include a yeast autonomous replication sequence (ARS). The yeast self-replicating sequence may be stabilized by a yeast centrometric sequence (CEN). The promoter may also be operatively linked to a nucleic acid encoding albumin. The promoter is covalently linked Cell Wall protein 12 (CCW12), glyceraldehyde-3-phosphate dehydrogenase (GPD), Pyruvate DeCarboxylase 1 (PDC1), phosphoglycerate kinase (PGK), transcription enhancer factor 1 (TEF1), glyceraldehyde-3-phosphate dehydrogenase (TDH), triose phosphate isomerase (TPI), purine-cytosine permease (PCPL3), GAL1, GAL10, CMV, EM7, and alcohol dehydrogenase (ADH) gene-derived promoters, but are not limited thereto. . The terminator may be selected from the group consisting of phosphoglycerate kinase 1 (PGK1), cytochrome c transcription (CYC1), and GAL1, but is not limited thereto.
상기 벡터는 플라스미드 벡터 또는 바이러스 벡터일 수 있으며, 재조합 벡터일 수 있다. 상기 재조합 바이러스 벡터는 아데노바이러스 벡터, 아데노 부속 바이러스 벡터, 렌티바이러스 벡터, 레트로바이러스 벡터 등일 수 있으나, 이에 제한되는 것은 아니다.The vector may be a plasmid vector or a viral vector, or may be a recombinant vector. The recombinant viral vector may be an adenoviral vector, adeno-associated viral vector, lentiviral vector, retroviral vector, etc., but is not limited thereto.
상기 벡터는 선택성 마커를 포함할 수 있다. 상기 마커는 통상적으로 화학적인 방법으로 선택될 수 있는 특성을 갖는 핵산 서열로, 형질전환된 세포를 비 형질전환 세포로부터 구별할 수 있는 모든 유전자가 이에 해당되며, 예를 들면, 앰피실린(Ampicillin), 카나마이신(Kanamycin), 제네티신(Geneticin; G418), 블레오마이신(Bleomycin), 하이그로마이신(Hygromycin), 클로람페니콜(Chloramphenicol) 등과 같은 항생제 내성 유전자가 있으나, 이에 제한되는 것은 아니다.The vector may include a selectable marker. The marker is a nucleic acid sequence having a characteristic that can be selected by a conventional chemical method, and includes all genes capable of distinguishing transformed cells from non-transformed cells, for example, ampicillin , Kanamycin, Geneticin (G418), Bleomycin, Hygromycin, Chloramphenicol, and the like, but antibiotic resistance genes, but are not limited thereto.
또한 본 발명은 상기 발현 벡터로 형질전환된 형질전환체를 제공한다.In addition, the present invention provides a transformant transformed with the expression vector.
상기 형질전환체는 상기 벡터를 안정되면서 연속적으로 클로닝 및 발현시킬 수 있는 임의의 숙주를 의미한다. 상기 형질전환체의 숙주는 사카로마이세스 (Saccharomyces), 피치아(Pichia), 클루이베로마이세스(Kluyveromyces), 캔디다 (Candida), 이사첸키아(Issatchenkia), 데바리오마이세스(Debaryomyces), 자이고사카로마이세스(Zygosaccharomyces), 쉬조사카로마이스세(Shizosaccharomyces), 사카로마이콥시스(Saccharomycopsis), 에스케리치아(Escherichia), 바실러스(Bacillus), 스트렙토마이세스(Streptomyces), 슈도모나스(Pseudomonas), 스타필로코쿠스(Staphylococcus) 등 일 수 있으나, 이에 제한되는 것은 아니다. 상기 현질전환체의 숙주는 예를 들면, 사카로마이세스 세레비지에(Saccharomyces cerevisiae), 피치아 파스토리스(Pichia pastoris), 에스케리치아 콜라이(Escherichia coli), 바실러스 서브틸리스(Bacillus Subtilis), 슈도모나스 푸티다(Pseudomonas putida), 스타필로코쿠스 카르노수스(Staphylocus carnosus)일 수 있다. 상기 현질전환체의 숙주는 인간을 제외한 것일 수 있다.The transformant refers to any host capable of continuously cloning and expressing the vector while being stable. The host of the transformant isSaccharomyces ,Pichia ,Kluyveromyces ,Candida ,Issatchenkia ,Debaryomyces , Zygosaka Roma Ises (Zygosaccharomyces ), Shizosaccharomyces (Shizosaccharomyces ), Saccharomycopsis (Saccharomycopsis ), Escherichia (Escherichia ), Bacillus (Bacillus ), Streptomyces (Streptomyces ), Pseudomonas (Pseudomonas ), Star Philococcus (Staphylococcus ) It may be the like, but is not limited thereto. The host of the transformant is, for example,Saccharomyces cerevisiae ,Pichia pastoris ,Escherichia coli ,Bacillus subtilis , Pseudomonas putida (Pseudomonas putida ), Staphylococcus carnosus (Staphylocus carnosus ). The host of the transgene may be other than human.
상기 형질전환체는 상기 발현 벡터를 당업계에 공지된 방법, 예를 들면, 일시적 형질감염(transient transfection), 미세주사, 형질도입(transduction), 세포융합, 칼슘 포스페이트 침전법, 리포좀 매개된 형질감염(liposome-mediated transfection), DEAE 덱스트란-매개된 형질감염(DEAE Dextran- mediated transfection), 폴리브렌-매개된 형질 감염(polybrene-mediated transfection), 전기침공법(electropora tion), 유전자 총(gene gun) 또는 세포 내로 핵산을 유입시키기 위한 다른 공지의 방법에 의해 숙주세포에 도입하여 수득할 수 있다(Wu et al., J. Bio. Chem., 267:963-967, 1992; Wu and Wu, J. Bio. Chem., 263:14621-14624, 1988).The transformant is prepared by using the expression vector by a method known in the art, for example, transient transfection, microinjection, transduction, cell fusion, calcium phosphate precipitation, liposome-mediated transfection. (liposome-mediated transfection), DEAE dextran-mediated transfection, polybrene-mediated transfection, electroporation, gene gun ) or by introducing into host cells by other known methods for introducing nucleic acids into cells (Wu et al., J. Bio. Chem., 267:963-967, 1992; Wu and Wu, J Bio.Chem., 263:14621-14624, 1988).
또한 본 발명은 상기 형질전환체를 배양하여 수득한 배양물을 제공한다.In addition, the present invention provides a culture obtained by culturing the transformant.
상기 배양물은 상기 현질전환체를 배지에서 배양하는 과정 중 또는 배양 후, 수득된 숙주 세포, 배양액 및 상층액으로 바이오매스(세포, 균체 등)를 포함하거나 포함하지 않은 것일 수 있고, 이를 원심분리, 여과 등의 과정을 거친 것 또는 별도의 과정을 거치지 않은 배양물 그대로인 것일 수 있다. 상기 배양물은 알부민을 다량 함유할 수 있다.The culture may be obtained during or after culturing the transformant in a medium, and may or may not contain biomass (cells, cells, etc.) as host cells, culture medium, and supernatant obtained by centrifugation It may be a product that has undergone a process such as filtration, filtration, or the like, or a culture product that has not undergone a separate process. The culture may contain high amounts of albumin.
또한 본 발명은 상기 배양물로부터 회수하는 알부민을 제공한다.In addition, the present invention provides albumin recovered from the culture.
배양물로부터의 알부민의 회수는, 통상적으로 알려진 분리 및 정제방법을 사용하여 수행할 수 있다.Recovery of albumin from the culture can be performed using commonly known separation and purification methods.
또한 본 발명은 상기 형질전환체를 배양하는 단계를 포함하는 알부민 생산 방법을 제공한다.In addition, the present invention provides an albumin production method comprising culturing the transformant.
상기 형질전환체의 배양은 관련 기술 분야에 공지된 적당한 배지와 배양조건에 따를 수 있다. 이러한 배양과정은 통상의 기술자라면 선택되는 균주에 따라 용이하게 조정하여 사용할 수 있다. 세포 배양은, 세포의 성장 방식에 따라 현탁배양과 부착배양, 배양방법에 따라 회분식, 유가식 및 연속배양식 등의 방법을 선택하여 수행할 수 있다. 상기 배지는 상기 형질전환체의 요구 조건을 만족하는 것일 수 있다. 상기 배지는 다양한 탄소원, 질소원 및 미량원소 성분을 포함할 수 있다. 기 탄소원은, 예를 들면, 포도당, 자당, 유당, 과당, 말토오스, 전분, 셀룰로오스와 같은 탄수화물, 대두유, 해바라기유, 피마자유, 코코넛유와 같은 지방, 팔미트산, 스테아린산, 리놀레산과 같은 지방산, 글리셀롤 및 에탄올과 같은 알코올, 아세트산과 같은 유기산, 및/또는 이들의 조합을 포함할 수 있다. 상기 배양은 예를 들면, 글루코스를 탄소원으로 하여 수행될 수 있다. 상기 질소원은, 예를 들면, 펩톤, 효모 추출물, 육즙, 맥아 추출물, 옥수수 침지액, 및 대두밀과 같은 유기 질소원 및 요소, 황산암모늄, 염화암모늄, 인산암모늄, 탄산암모늄 및 질산암모늄과 같은 무기 질소원, 및/또는 이들의 조합을 포함할 수 있다. 상기 배지는 인의 공급원으로서, 예를 들면, 인산이수소칼륨, 인산수소이칼륨 및 상응하는 소듐-함유 염, 황산마그네슘 또는 황산철과 같은 금속염을 포함할 수 있다. 또한, 아미노산, 비타민, 및 적절한 전구체 등이 배지에 포함될 수 있다. 상기 배지 또는 개별 성분은 배양액에 회분식 또는 연속식으로 첨가될 수 있다. 또한, 배양 중에 수산화암모늄, 수산화칼륨, 암모니아, 인산 및 황산과 같은 화합물을 미생물 배양액에 적절한 방식으로 첨가하여 배양액의 pH를 조정할 수 있다. 또한, 배양 중에 지방산 폴리글리콜 에스테르와 같은 소포제를 사용하여 기포 생성을 억제할 수 있다.Cultivation of the transformant may be performed according to appropriate media and culture conditions known in the related art. This culturing process can be easily adjusted and used by those skilled in the art according to the selected strain. Cell culture may be carried out by selecting methods such as suspension culture and attached culture according to the growth method of cells, and batch, fed-batch and continuous culture according to the culture method. The medium may satisfy the requirements of the transformant. The medium may contain various carbon sources, nitrogen sources, and trace element components. Carbon sources include, for example, glucose, sucrose, lactose, fructose, maltose, starch, carbohydrates such as cellulose, fats such as soybean oil, sunflower oil, castor oil, and coconut oil, fatty acids such as palmitic acid, stearic acid, and linoleic acid, alcohols such as glycerol and ethanol, organic acids such as acetic acid, and/or combinations thereof. The culturing may be performed using, for example, glucose as a carbon source. The nitrogen source is, for example, organic nitrogen sources and elements such as peptone, yeast extract, broth, malt extract, corn steep liquor, and soybean wheat, inorganic nitrogen sources such as ammonium sulfate, ammonium chloride, ammonium phosphate, ammonium carbonate and ammonium nitrate, and/or combinations thereof. As a source of phosphorus, the medium may contain, for example, potassium dihydrogen phosphate, dipotassium hydrogen phosphate and corresponding sodium-containing salts, metal salts such as magnesium sulfate or iron sulfate. In addition, amino acids, vitamins, and appropriate precursors may be included in the medium. The medium or individual components may be added to the culture in a batch or continuous manner. In addition, the pH of the culture solution can be adjusted by adding compounds such as ammonium hydroxide, potassium hydroxide, ammonia, phosphoric acid and sulfuric acid to the microbial culture solution in an appropriate manner during cultivation. In addition, the formation of bubbles can be suppressed by using an antifoaming agent such as a fatty acid polyglycol ester during cultivation.
상기 형질전환체는 호기, 미호기, 또는 혐기 조건에서 배양될 수 있다. 상기 미호기 조건은 대기 중 산소의 수준보다 낮은 수준의 산소가 배지 중으로 용해되는 배양 조건을 의미한다. 상기 낮은 수준의 산소는 예를 들면, 대기에 대한 포화 용존 산소 농도의 0.1% 내지 10%, 1% 내지 9%, 2% 내지 8%, 3% 내지 7%, 또는 4 내지 6%일 수 있다. 또한, 미호기 조건은 예를 들면, 배지 중의 용존 산소 농도가 0.9 ppm에서 3.6 ppm인 것일 수 있다. 배양 온도는 예를 들면, 20℃ 내지 45℃, 25℃ 내지 40℃ 또는 27℃ 내지 35℃일 수 있다. 배양 기간은 원하는 알부민이 원하는 양으로 얻어질 때까지 지속할 수 있으며, 12시간 내지 350시간, 30시간 내지 180시간, 50시간 내지 110시간 또는 60시간 내지 80시간일 수 있다.The transformant may be cultured under aerobic, non-aerobic, or anaerobic conditions. The microaerobic conditions refer to culture conditions in which oxygen at a level lower than the level of oxygen in the atmosphere is dissolved into the medium. The low level of oxygen can be, for example, 0.1% to 10%, 1% to 9%, 2% to 8%, 3% to 7%, or 4 to 6% of the saturated dissolved oxygen concentration relative to the atmosphere. . In addition, the microaerobic condition may be, for example, that the concentration of dissolved oxygen in the medium is 0.9 ppm to 3.6 ppm. The incubation temperature may be, for example, 20 °C to 45 °C, 25 °C to 40 °C or 27 °C to 35 °C. The culture period may last until the desired amount of albumin is obtained, and may be 12 hours to 350 hours, 30 hours to 180 hours, 50 hours to 110 hours, or 60 hours to 80 hours.
상기 알부민 생산 방법은 배양물로부터 알부민을 회수 또는 분리하는 단계를 포함할 수 있다.The albumin production method may include recovering or isolating albumin from the culture.
배양물로부터의 알부민의 회수는, 통상적으로 알려진 분리 및 정제방법을 사용하여 수행할 수 있다. 상기 회수는 원심분리, 이온교환 크로마토그래피, 여과, 침전, 추출, 증류 등에 의할 수 있다. 예를 들면, 배양물을 원심분리하여 바이오 매스를 제거하고, 얻어진 상등액을 바로 이용하거나 크로마토그래피를 통하여 분리하여 사용할 수 있다. 상기 형질전환체는 알부민을 높은 수율로 생산할 수 있다.Recovery of albumin from the culture can be performed using commonly known separation and purification methods. The recovery may be performed by centrifugation, ion exchange chromatography, filtration, precipitation, extraction, distillation, and the like. For example, the culture is centrifuged to remove biomass, and the obtained supernatant may be used directly or separated through chromatography. The transformant can produce albumin in high yield.
또한 본 발명은 상기 배양물을 포함하는 식품 조성물을 제공한다.In addition, the present invention provides a food composition comprising the culture.
상기 식품 조성물은 알부민을 함유할 수 있다. 상기 식품 조성물은 분말, 과립, 정제, 캡슐, 시럽, 음료 또는 환의 형태일 수 있으며, 상기 식품 조성물은 유효 성분 이외에 다른 식품 또는 식품 첨가물과 함께 사용할 수 있다. 유효 성분의 혼합양은 그의 사용 목적, 예를 들면 예방, 건강 또는 치료적 처치에 따라 적합하게 결정할 수 있다.The food composition may contain albumin. The food composition may be in the form of a powder, granule, tablet, capsule, syrup, drink or pill, and the food composition may be used with other food or food additives in addition to the active ingredient. The mixing amount of the active ingredient can be appropriately determined depending on the purpose of its use, for example, prevention, health or therapeutic treatment.
상기 식품 조성물에 함유된 알부민의 유효량은 상기 약학 조성물의 유효량에 준해서 사용할 수 있으나, 건강 및 위생을 목적으로 하거나 또는 건강 조절을 목적으로 하는 장기간의 섭취의 경우에는 상기 범위 이하일 수 있으며, 유효 성분은 안전성 면에서 아무런 문제가 없기 때문에 상기 범위 이상의 양으로도 사용할 수 있다.The effective amount of albumin contained in the food composition may be used according to the effective amount of the pharmaceutical composition, but may be less than the above range in the case of long-term intake for the purpose of health and hygiene or health control, and the active ingredient Since there is no problem in terms of safety, it can be used in an amount greater than the above range.
상기 식품 조성물의 종류는 특별한 제한되는 것은 아니며, 예를 들면, 육류, 소세지, 빵, 쵸코렛, 캔디류, 스넥류, 과자류, 피자, 라면, 기타 면류, 껌류, 아이스크림류를 포함한 낙농제품, 각종 스프, 음료수, 차, 드링크제, 알콜 음료, 비타민 복합제 등일 수 있다.The type of the food composition is not particularly limited, for example, meat, sausage, bread, chocolate, candy, snacks, confectionery, pizza, ramen, other noodles, gum, dairy products including ice cream, various soups, and beverages , tea, drinks, alcoholic beverages, vitamin complexes, and the like.
또한 본 발명은 배양물을 포함하는 화장품 조성물을 제공한다.In addition, the present invention provides a cosmetic composition containing the culture.
상기 화장품 조성물은 알부민을 함유할 수 있다. 상기 화장품 조성물은 유효 성분 외에 안정화제, 용해화제, 비타민, 안료, 향료 등과 같은 통상적인 보조제, 그리고 담체를 포함할 수 있다.The cosmetic composition may contain albumin. The cosmetic composition may include conventional adjuvants such as stabilizers, solubilizers, vitamins, pigments, fragrances, and the like, and carriers in addition to active ingredients.
상기 화장품 조성물의 제형은 당업계에서 통상적으로 제조되는 어떠한 제형으로도 제조될 수 있으며, 피부외용 연고, 크림, 유연화장수, 영양화장수, 팩, 에센스, 헤어토닉, 샴푸, 린스, 헤어 컨디셔너, 헤어 트리트먼트, 젤, 스킨 로션, 스킨소프너, 스킨토너, 아스트린젠트, 로션, 밀크로션, 모이스처 로션, 영양로션, 마사지 크림, 영양크림, 아이크림, 모이스처 크림, 핸드 크림, 파운데이션, 영양에센스, 선스크린, 비누, 클렌징폼, 클렌징로션, 클렌징크림, 바디 로션 및 바디 클렌저로 이루어지는 군에서 선택된 하나 이상의 제형을 가질 수 있으나, 이에 제한되는 것은 아니다. 상기 화잘품 조성물은 그 제형의 제제화에 필요하고 적절한 각종의 기제와 첨가물을 함유할 수 있으며, 이들 성분의 종류와 양은 당업자에 의해 용이하게 선정될 수 있다.The formulation of the cosmetic composition may be prepared in any formulation conventionally prepared in the art, and external skin ointments, creams, softening lotions, nutrient lotions, packs, essences, hair tonics, shampoos, conditioners, hair conditioners, and hair treatments Treatment, gel, skin lotion, skin softener, skin toner, astringent, lotion, milk lotion, moisture lotion, nutrition lotion, massage cream, nutrition cream, eye cream, moisture cream, hand cream, foundation, nutrition essence, sunscreen, soap , It may have one or more formulations selected from the group consisting of cleansing foam, cleansing lotion, cleansing cream, body lotion and body cleanser, but is not limited thereto. The chemical composition may contain various bases and additives necessary and appropriate for the formulation of the formulation, and the types and amounts of these components can be easily selected by those skilled in the art.
상기 제형이 페이스트, 크림 또는 겔인 경우에는 담체 성분으로서 동물성유, 식물성유, 왁스, 파라핀, 전분, 트라칸트, 셀룰로오스 유도체, 폴리에틸렌 글리콜, 실리콘, 벤토나이트, 실리카, 탈크 또는 산화아연 등이 이용될 수 있다. 상기 제형이 파우더 또는 스프레이인 경우에는 담체 성분으로서 락토스, 탈크, 실리카, 알루미늄 히드록시드, 칼슘 실리케이트 또는 폴리아미드 파우더를 이용할 수 있고, 특히 스프레이인 경우에는 추가적으로 클로로플루오로히드로카본, 프로판/부탄 또는 디메틸 에테르와 같은 추진체를 포함할 수 있다. 상기 제형이 용액 또는 유탁액인 경우에는 담체 성분으로서 용매, 용해화제 또는 유탁화제를 이용할 수 있고, 예를 들면, 물, 에탄올, 이소프로판올, 에틸 카보네이트, 에틸 아세테이트, 벤질 알코올, 벤질 벤조에이트, 프로필렌 글리콜, 1,3-부틸글리콜 오일, 글리세롤 지방족 에스테르, 폴리에틸렌 글리콜 또는 소르비탄의 지방산 에스테르를 포함할 수 있다. 상기 제형이 현탁액인 경우에는 담체 성분으로서 물, 에탄올 또는 프로필렌 글리콜과 같은 액상의 희석제, 에톡실화 이소스테아릴 알코올, 폴리옥시에틸렌 소르비톨 에스테르 및 폴리옥시에틸렌 소르비탄 에스테르와 같은 현탁제, 미소결정성 셀룰로오스, 알루미늄 메타히드록시드, 벤토나이트, 아가 또는 트라칸트 등을 이용할 수 있다.When the formulation is a paste, cream or gel, animal oil, vegetable oil, wax, paraffin, starch, tracanth, cellulose derivative, polyethylene glycol, silicone, bentonite, silica, talc or zinc oxide may be used as a carrier component. . When the formulation is a powder or spray, lactose, talc, silica, aluminum hydroxide, calcium silicate or polyamide powder may be used as a carrier component, and in particular, in the case of a spray, additionally chlorofluorohydrocarbon, propane/butane or propellants such as dimethyl ether. When the formulation is a solution or emulsion, a solvent, solubilizing agent or emulsifying agent may be used as a carrier component, for example, water, ethanol, isopropanol, ethyl carbonate, ethyl acetate, benzyl alcohol, benzyl benzoate, propylene glycol , 1,3-butyl glycol oil, glycerol aliphatic esters, polyethylene glycol or sorbitan fatty acid esters. When the formulation is a suspension, a liquid diluent such as water, ethanol or propylene glycol, a suspending agent such as ethoxylated isostearyl alcohol, polyoxyethylene sorbitol ester and polyoxyethylene sorbitan ester, microcrystalline cellulose as a carrier component , aluminum metahydroxide, bentonite, agar or tracanth and the like can be used.
또한 본 발명은 상기 배양물을 포함하는 약학 조성물을 제공한다.In addition, the present invention provides a pharmaceutical composition comprising the culture.
상기 약학 조성물은 알부민을 함유할 수 있다. 유효 성분으로 알부민을 필요로 하는 경우 적용가능하다. 상기 약학 조성물은 유효 성분 이외에 약제학적으로 적합하고 생리학적으로 허용되는 보조제를 포함할 수 있으며, 상기 보조제로는 부형제, 붕해제, 감미제, 결합제, 피복제, 팽창제, 윤활제, 활택제 또는 향미제 등의 가용화제를 사용할 수 있다. 상기 약학 조성물은 투여를 위해서 유효 성분 이외에 추가로 약제학적으로 허용 가능한 담체를 1 종 이상 포함하여 제제화할 수 있다. 액상 용액으로 제제화 하기 위한 담체로는, 멸균 및 생체에 적합한 것으로서, 식염수, 멸균수, 링거액, 완충 식염수, 알부민 주사용액, 덱스트로즈 용액, 말토 덱스트린 용액, 글리세롤, 에탄올 및 이들 성분 중 1 성분 이상을 혼합하여 사용할 수 있으며, 필요에 따라 항산화제, 완충액, 정균제 등 다른 통상의 첨가제를 첨가할 수 있다. 또한 희석제, 분산제, 계면활성제, 결합제 및 윤활제를 부가적으로 첨가하여 수용액, 현탁액, 유탁액 등과 같은 주사용 제형, 환약, 캡슐, 과립 또는 정제로 제제화할 수 있다.The pharmaceutical composition may contain albumin. It is applicable when albumin is required as an active ingredient. The pharmaceutical composition may include pharmaceutically suitable and physiologically acceptable adjuvants in addition to active ingredients, such as excipients, disintegrants, sweeteners, binders, coating agents, expanding agents, lubricants, lubricants, or flavoring agents. of solubilizers can be used. The pharmaceutical composition may be formulated by including one or more pharmaceutically acceptable carriers in addition to the active ingredient for administration. The carrier for formulation as a liquid solution is sterile and biocompatible, and includes saline, sterile water, Ringer's solution, buffered saline, albumin injection solution, dextrose solution, maltodextrin solution, glycerol, ethanol, and at least one of these components. may be mixed and used, and other conventional additives such as antioxidants, buffers, and bacteriostatic agents may be added if necessary. In addition, diluents, dispersants, surfactants, binders, and lubricants may be additionally added to prepare formulations for injections such as aqueous solutions, suspensions, and emulsions, pills, capsules, granules, or tablets.
상기 약학 조성물의 약제 제제 형태는 과립제, 산제, 피복정, 정제, 캡슐제, 좌제, 시럽, 즙, 현탁제, 유제, 점적제 또는 주사 가능한 액제 및 활성 화합물의 서방출형 제제 등일 수 있다. 상기 약학 조성물은 정맥내, 동맥내, 복강내, 근육내, 동맥내, 복강내, 흉골내, 경피, 비측내, 흡입, 국소, 직장, 경구, 안구내 또는 피내 경로를 통해 통상적인 방식으로 투여할 수 있다.The pharmaceutical formulation form of the pharmaceutical composition may be granules, powders, coated tablets, tablets, capsules, suppositories, syrups, juices, suspensions, emulsions, drops or injectable solutions, and sustained-release formulations of active compounds. The pharmaceutical composition is administered in a conventional manner via intravenous, intraarterial, intraperitoneal, intramuscular, intraarterial, intraperitoneal, intrasternal, transdermal, intranasal, inhalational, topical, rectal, oral, intraocular or intradermal routes. can do.
상기 약학 조성물의 유효 성분의 유효량은 질환의 예방 또는 치료 요구되는 양을 의미한다. 따라서, 유효량은 질환의 종류, 질환의 중증도, 조성물에 함유된 유효 성분 및 다른 성분의 종류 및 함량, 제형의 종류 및 환자의 연령, 체중, 일반 건강 상태, 성별 및 식이, 투여 시간, 투여 경로 및 조성물의 분비율, 치료 기간, 동시 사용되는 약물을 비롯한 다양한 인자에 따라 조절할 수 있다. 이에 제한되는 것은 아니나, 예컨대, 0.1 내지 2.0 ㎎/㎏의 양을 1일 1회 내지 수회 투여할 수 있다. An effective amount of the active ingredient of the pharmaceutical composition means an amount required for preventing or treating a disease. Therefore, the effective amount depends on the type of disease, the severity of the disease, the type and amount of the active ingredient and other ingredients contained in the composition, the type of formulation and the patient's age, weight, general health condition, sex and diet, administration time, administration route and It can be adjusted according to various factors including the secretion rate of the composition, the duration of treatment, and drugs used concurrently. Although not limited thereto, for example, an amount of 0.1 to 2.0 mg/kg may be administered once to several times a day.
이하에서는, 본 발명을 한정하지 않는 실시예에 따라 본 발명을 상세히 설명한다. 본 발명의 하기 실시예는 본 발명을 구체화하기 위한 것일 뿐 본 발명의 권리범위를 제한하거나 한정하는 것이 아님은 물론이다. 따라서, 본 발명의 상세한 설명 및 실시예로부터 본 발명이 속하는 기술분야의 전문가가 용이하게 유추할 수 있는 것은 본 발명의 권리범위에 속하는 것으로 해석된다.Hereinafter, the present invention will be described in detail according to examples that do not limit the present invention. Of course, the following examples of the present invention are only intended to embody the present invention and are not intended to limit or limit the scope of the present invention. Therefore, what can be easily inferred by an expert in the technical field to which the present invention belongs from the detailed description and examples of the present invention is interpreted as belonging to the scope of the present invention.
<실시예 1> 알부민 발현 유전자 설계, 발현 벡터 및 형질전환체 제작<Example 1> Albumin expression gene design, expression vector and transformant construction
미생물에서 알부민(albumin) 단백질을 발현하기 위하여 pPICZaA-ALB와 pESC-URA-ALB 플라스미드를 제작하였다. pPICZaA-ALB, pESC-URA-ALB의 제작은 NEB(MA, USE)사의 Gibson 어셈블리 키트를 사용하였다. 플라스미드의 클로닝(cloning)과 복제에는E. coliTOP10 균주를 사용하였다.To express albumin protein in microorganisms, pPICZaA-ALB and pESC-URA-ALB plasmids were constructed. For the production of pPICZaA-ALB and pESC-URA-ALB, a Gibson assembly kit from NEB (MA, USE) was used.E. coli TOP10 strain was used for cloning and cloning of the plasmid.
알부민 유전자는 식용 작물에서 알부민 유전자를 탐색하고 표 1, 3 및 4의 서열을 확보하였다.Albumin genes were searched for albumin genes in food crops and the sequences in Tables 1, 3 and 4 were obtained.
GlycineGlycine max max 2S 알부민 2S albumin
대두(soybean)soybean
GlycineGlycine max max
알부민-1albumin-1
(Q39837)(Q39837)
CicerCicerarietinumarietinum S2 S2
알부민 유사albumin-like
병아리콩chickpeas(chickpea)(chickpea)
CicerCicerarietinumarietinum
알부민-1 유사albumin-1 like
병아리콩chickpeas(chickpea)(chickpea)
CicerCicerarietinumarietinum
알부민-2 유사albumin-2 like
VignaVignaradiataradiataS2S2
알부민 유사albumin-like
녹두(green gram(MungMung bean) beans)
VignaVignaradiataradiata
알부민-1 유사albumin-1 like
녹두(green gram(MungMung bean) beans)
VignaVignaradiataradiata
알부민-2 유사albumin-2 like
알부민 유전자는 gblock으로 효모(yeast)에서 발현될 수 있도록 코돈 최적화하여 제작하였다. 벡터에 서열번호 17의 서열을 포함하는 핵산을 이용하고, 서열번호 1의 아미노산 서열이 발현되도록 하였다.The albumin gene was produced by optimizing the codon so that it can be expressed in yeast with gblock. A nucleic acid containing the sequence of SEQ ID NO: 17 was used as a vector, and the amino acid sequence of SEQ ID NO: 1 was expressed.
먼저, pPICZaA-ALB는 pPICZaA 벡터의 알파 팩터 시그널 서열(Alpha factor signal sequence) 뒤에 알부민 유전자를 클로닝하고 pPICZaA 플라스미드를 pPICZaA 백본(backbone) F 프라이머 및 pPICZaA 백본(backbone) R 프라이머(서열번호 27 및 28)로 PCR 하여 제작하였다. 이후 SacI 효소를 이용하여 pPICZaA-ALB를 선형화하고P. pastoris의 유전자에 넣어 형질전환하였다. pESC-URA-ALB는 BamHI 제한효소를 이용하여 pESC-URA 플라스미드를 자르고 그 자리에 알부민 유전자를 Gibson 어셈블리 방법으로 삽입하여 제작하였다. 자세한 실험 방법은 어셈블리 키트 프로토콜을 따랐다. pPICZaA-ALB 플라스미드는P. pastoris의 발현 벡터로 사용하였고, pESC-URA-ALB 플라스미드는S. cerevisiae발현 벡터로 사용하였다.First, pPICZaA-ALB cloned the albumin gene behind the Alpha factor signal sequence of the pPICZaA vector, and the pPICZaA plasmid was prepared using pPICZaA backbone F primer and pPICZaA backbone R primer (SEQ ID NOs: 27 and 28) It was prepared by PCR. Then, pPICZaA-ALB was linearized using SacI enzyme and transformed intothe P. pastoris gene. pESC-URA-ALB was prepared by cutting the pESC-URA plasmid using BamHI restriction enzyme and inserting the albumin gene in its place using the Gibson assembly method. The detailed experimental method followed the assembly kit protocol. The pPICZaA-ALB plasmid was used as an expression vector forP. pastoris , and the pESC-URA-ALB plasmid was used as an expression vectorfor S. cerevisiae .
P. pastoris의 형질전환은 pPICZaA-ALB 플라스미드를 SacI 제한효소를 이용하여 선형(linear)으로 만든 뒤 형질전환(transformation) 하였으며, Pichia 발현 키트에 제시된 방법을 따랐다. S. cerevisiae의 형질전환은 LiAc/SS 캐리어 DNA/PEG를 사용하는 고효율 효모 형질전환 방법(High-efficiency yeast transformation using the LiAc/SS carrier DNA/PEG method, R Daniel Gietz & Robert H Schiestl, 2007, NATURE PROTOCOLS)을 따랐다.For transformation ofP. pastoris , the pPICZaA-ALB plasmid was made linear using SacI restriction enzyme and then transformed, following the method suggested in the Pichia expression kit.S. cerevisiae transformation using the LiAc/SS carrier DNA/PEG method (High-efficiency yeast transformation using the LiAc/SS carrier DNA/PEG method, R Daniel Gietz & Robert H Schiestl, 2007, NATURE PROTOCOLS) followed
시료의 출처, 사용된 프라이머, 알부민 유전자 및 코돈 최적화된 알부민(ALB) 서열은 표 2 내지 5와 같다.The source of the sample, the primers used, the albumin gene and the codon-optimized albumin (ALB) sequence are shown in Tables 2 to 5.
cerevisiaeCEN.PK 2-1CSaccharomyces
cerevisiae CEN.PK 2-1C
2-1C/pESC-URAS. cerevisiae CEN.PK
2-1C/pESC-URA
2-1C/pESC-URA-ALBS. cerevisiae CEN.PK
2-1C/pESC-URA-ALB
pPICZaAP. pastoris X33/
pPICZaA
pPICZaA-ALBP. pastoris X33/
pPICZaA-ALB
Glycine maxGlycine max 2S 알부민 2S albumin
대두(soybean)soybean
Glycine maxGlycine max
알부민-1albumin-1
(Q39837)(Q39837)
Cicer arietinumCicer arietinum S2 S2
알부민 유사albumin-like
병아리콩(chickpea)chickpea
Cicer arietinumCicer arietinum
알부민-1 유사albumin-1 like
병아리콩(chickpea)chickpea
Cicer arietinumCicer arietinum
알부민-2 유사albumin-2 like
Vigna radiataVigna radiataS2S2
알부민 유사albumin-like
녹두(Mung bean)Mung bean
Vigna radiataVigna radiata
알부민-1 유사albumin-1 like
녹두(Mung bean)Mung bean
Vigna radiataVigna radiata
알부민-2 유사albumin-2 like
Glycine maxGlycine max 2S 알부민 2S albumin
(코돈 최적화)(codon optimization)
대두(soybean)soybean
Glycine maxGlycine max
알부민-1albumin-1
(코돈 최적화)(codon optimization)
Cicer arietinumCicer arietinum S2 S2
알부민 유사albumin-like
(코돈 최적화)(codon optimization)
병아리콩(chickpea)chickpea
Cicer arietinumCicer arietinum
알부민-1 유사albumin-1 like
(코돈 최적화)(codon optimization)
병아리콩(chickpea)chickpea
Cicer arietinumCicer arietinum
알부민-2 유사albumin-2 like
(코돈 최적화)(codon optimization)
Vigna radiataVigna radiataS2S2
알부민 유사albumin-like
(코돈 최적화)(codon optimization)
녹두(Mung bean)Mung bean
Vigna radiataVigna radiata
알부민-1 유사albumin-1 like
(코돈 최적화)(codon optimization)
녹두(Mung bean)Mung bean
Vigna radiataVigna radiata
알부민-2 유사albumin-2 like
(코돈 최적화)(codon optimization)
서열번호 25SEQ ID NO: 25
서열번호 26SEQ ID NO: 26
서열번호 27SEQ ID NO: 27
서열번호 28SEQ ID NO: 28
서열번호 29SEQ ID NO: 29
서열번호 30SEQ ID NO: 30
도 1은 a) pPICZaA, b) pPICZaA-ALB, c) pESC-URA, d) pESC-URA-ALB 벡터 구조를 나타낸 것이다. 알부민을 생산하기 위해, 벡터가 형질전환된S.cerevisiae CEN.PK 2-1C/pESC-URA-ALB와P. pastoris X33/pPICZaA-ALB 균주를 발현 균주로 사용하였고,S. cerevisiae CEN.PK 2-1C/pESC-URA와P. pastoris X33/pPICZaA를 대조군 균주로 사용하였다.Figure 1 shows the structure of a) pPICZaA, b) pPICZaA-ALB, c) pESC-URA, and d) pESC-URA-ALB. To produce albumin, vector-transformedS.cerevisiae CEN.PK 2-1C/pESC-URA-ALB andP. pastoris X33/pPICZaA-ALB strains were used as expression strains, andS. cerevisiae CEN.PK 2 -1C/pESC-URA andP. pastoris X33/pPICZaA were used as control strains.
도 2a는Pichia pastoris에서 Glycine Max의 알부민 코돈 최적화된(codon optimized) 서열을 포함하는 알부민 발현 플라스미드와Pichia pastoris 형질전환체의 구조를 나타낸 것이다. 플라스미드 pPICZaA-ALB를 제한효소(Sac I)으로 선형화한 다음,P. pastoris유전자 내로 도입하여 형질전환하였다. 도 2b는 프로모터, 시그널 펩타이드, 알부민 유전자, 종결 서열 및 마커를 포함하는 카세트 구조를 나타낸 것이다.Figure 2a shows the structure of an albumin expression plasmid containing an albumin codon optimized sequence of Glycine Max inPichia pastoris anda Pichia pastoris transformant. The plasmid pPICZaA-ALB was linearized with restriction enzyme (Sac I) and then introduced intothe P. pastoris gene to transform it. Figure 2b shows the structure of the cassette including the promoter, signal peptide, albumin gene, termination sequence and marker.
이 후 콜로니 중합효소 연쇄반응(pcr polymerase chain reaction: PCR)을 이용하여 형질전환이 확인된 균주만 사용하였다. 도 3a는 알부민 발현 벡터로 형질전환된 알부민 생산 균주의 콜로니를 나타낸 것이다. a는 알부민 생성 플라스미드가 없는S. cerevisiae대조군의 플레이트; b는 알부민 생산 플라스미드(pESC-URA-ALB)를 갖는 S. cerevisiae 균주의 플레이트 및 콜로니; c는 알부민 생성 플라스미드가 없는P. pastoris대조군의 플레이트; d는 알부민 생성 플라스미드(pPICZaA-ALB)를 갖는P. pastoris균주의 플레이트 및 콜로니를 나타낸 것이다. 도 3b는 이의 배양액 및 폴리아크릴아마이드 겔 전기 영동법(sodium dodecyl sulphate-polyacrylamide gel electrophoresis: SDS-PAGE)으로 산물을 확인한 결과이다.Then, only strains whose transformation was confirmed using colony polymerase chain reaction (PCR) were used. Figure 3a shows colonies of albumin-producing strains transformed with albumin expression vectors. a,S. cerevisiae control plate without albumin production plasmid; b, plates and colonies ofS. cerevisiae strains with an albumin production plasmid (pESC-URA-ALB); c plate ofP. pastoris control without albumin producing plasmid; d shows plates and colonies ofP. pastoris strains carrying the albumin producing plasmid (pPICZaA-ALB). Figure 3b is the result of confirming the product by the culture solution and polyacrylamide gel electrophoresis (sodium dodecyl sulphate-polyacrylamide gel electrophoresis: SDS-PAGE).
<실시예 2> 알부민 발현 형질전환체 배양 및 이의 배양액에서의 난백 유사 물성-버블 생성 확인<Example 2> Culture of albumin-expressing transformant and egg white-like physical properties in the culture solution - Confirmation of bubble formation
실시예 1에서 제작한 알부민 발현 형질전환체S. cerevisiae CEN.PK 2-1C/pESC-URA-ALB와P. pastoris X33/pPICZaA-ALB를 배양하고, 계란 흰자와 유사한 물성을 나타내는지 확인하였다.The albumin-expressing transformants prepared in Example 1,S. cerevisiae CEN.PK 2-1C/pESC-URA-ALB andP. pastoris X33/pPICZaA-ALB, were cultured, and it was confirmed whether they exhibited properties similar to those of egg white.
E. coli TOP10으로부터 플라스미드를 얻기 위하여 Lysogeny Broth(LB) 배지(5g/ℓ 효모 추출물, 10g/ℓ 트립톤 및 10g/ℓ NaCl)에 50㎍/㎖의 앰피실린(ampicilin)을 첨가하여 배앙하였다.To obtain a plasmid fromE. coli TOP10, 50 μg/ml ampicillin was added to Lysogeny Broth (LB) medium (5 g/L yeast extract, 10 g/L tryptone, and 10 g/L NaCl) and cultured.
S. cerevisiae의 전배양에 최소(SC) 배지(6.7g/ℓ 아미노산을 함유하지 않은 효모 나이트로젠 베이스(yeast nitrogen base) 및 0.6g/ℓ 히스티딘(histidine), 류신(leucine), 트립토판(tryptophan) 및 우라실(uracil)을 함유하지 않은 완전 보충제 혼합물(complete supplement mixture))을 이용하였다.S. cerevisiae CEN.PK 2-1C/pESC-URA-ALB의 발현 배지는 YP 배지(10g/ℓ 효모 추출물 및 20g/ℓ 펩톤)에 20g/ℓ 갈락토스(galactose)를 첨가한 것을 이용하였다. 알부민 발현을 위하여 OD600=1로 맞추어 접종하였으며 30℃, 200rpm으로 72h동안 배양하였다.A minimal (SC) medium (6.7 g/L yeast nitrogen base without amino acids and 0.6 g/L histidine, leucine, tryptophan) was added to the preculture ofS. cerevisiae . and a complete supplement mixture that does not contain uracil. As a medium for expressingS. cerevisiae CEN.PK 2-1C/pESC-URA-ALB, a medium in which 20 g/L galactose was added to YP medium (10 g/L yeast extract and 20 g/L peptone) was used. For albumin expression, it was inoculated at OD600 = 1 and cultured for 72 h at 30 ° C and 200 rpm.
P. pastoris X33/pPICZaA-ALB의 전배양에 완충 글리세롤 복합 배지(Buffered Glycerol complex medium: BMGY, 1% 효모 추출물, 2% 펩톤, 100mM 포타슘 포스페이트(pH 6.0), 1.34% 효모 나이트로젠 베이스, 0.00004% 비오틴 및 1% 글리세롤)에 ZeocinTM 100㎍/㎖을 첨가한 것을 이용하였다.P.pastoris X33/pPICZaA-ALB 발현 배지는 완충 메탄올 복합 배지(Buffered Methanol complex medium:BMMY, 1% 효모 추출물, 2% 펩톤, 100mM 포타슘 포스페이트(pH 6.0), 1.34% 효모 나이트로젠 베이스, 0.00004% 비오틴 및 0.5% 메탄올)를 이용하였다. 알부민 발현을 위하여 OD600=1로 맞추어 접종하였으며 30℃, 200rpm으로 72h동안 배양하였다.Buffered Glycerol complex medium (BMGY, 1% yeast extract, 2% peptone, 100 mM potassium phosphate (pH 6.0), 1.34% yeast nitrogen base, 0.00004% yeast nitrogen base, 0.00004%P. pastoris X33/pPICZaA-ALB preculture) Biotin and 1% glycerol) was used in which 100 μg/ml of ZeocinTM was added.P.pastoris X33/pPICZaA-ALB expression medium was buffered methanol complex medium (BMMY, 1% yeast extract, 2% peptone, 100 mM potassium phosphate (pH 6.0), 1.34% yeast nitrogen base, 0.00004% biotin). and 0.5% methanol) were used. For albumin expression, it was inoculated at OD600 = 1 and cultured for 72 h at 30 ° C and 200 rpm.
알부민 발현 형질전환체를 배양하는 과정에서 배양액에 알부민을 포함하는 단백질이 다량 함유될 것으로 예상하였다. 배양액이 계란 흰자와 유사한 물성을 나타내는지 확인하기 위하여 버블 생성 정도를 관찰하였다.In the process of culturing the albumin-expressing transformant, it was expected that a large amount of albumin-containing proteins would be contained in the culture medium. The degree of bubble generation was observed to confirm that the culture medium exhibited properties similar to those of egg white.
도 4는 알부민 발현 벡터로 형질전환된 알부민 생산 균주의 배양액과 대조군 균주의 배양액에서 버블 생성 정도를 나타낸 것이다. 도 4a를 참고하면, 오른쪽에 나타낸 알부민 생산 균주인 S. cerevisiae CEN.PK2-1C/pESC-URA-ALB의 배양액은 왼쪽에 나타낸 대조군 균주인S. cerevisiaeCEN.PK2-1C/pESC-URA의 배양액에 비해 계란 흰자의 성질과 유사한 버블이 더 많이 생성되었다. 도 4b를 참고하면, 오른쪽에 나타낸 알부민 생산 균주인P. pastoris X33/pPICZaA-ALB 배양액의 상등액은 왼쪽에 나타낸P. pastoris X33/pPICZaA 배양액의 상등액에 비해 계란 흰자의 성질과 유사한 버블이 더 많이 생성되었다.Figure 4 shows the degree of bubble formation in the culture medium of the albumin-producing strain transformed with the albumin expression vector and the culture medium of the control strain. Referring to Figure 4a, the culture medium of the albumin-producing strainS. cerevisiae CEN.PK2-1C / pESC-URA-ALB shown on the right is the culture medium of the control strainS. cerevisiae CEN.PK2-1C / pESC-URA shown on the left Compared to , more bubbles similar to the properties of egg white were created. Referring to Figure 4b, the supernatant ofthe P. pastoris X33 / pPICZaA-ALB culture medium, which is an albumin-producing strain shown on the right, produces more bubbles similar to the properties of egg whites than the supernatant ofthe P. pastoris X33 / pPICZaA culture medium shown on the left. It became.
도 5는 알부민 발현 벡터로 형질전환된 알부민 생산 균주의 배양액과 대조군 균주의 배양액에서 상등액을 취한 후 버블 생성 정도를 나타낸 것이다. 오른쪽에 나타낸 알부민 생산 균주인S. cerevisiae CEN.PK2-1C/pESC-URA-ALB 배양액의 상등액은 왼쪽에 나타낸S. cerevisiae CEN.PK2-1C/pESC-URA 배양액의 상등액에 비해 계란 흰자의 성질과 유사한 버블이 더 많이 생성되었다.Figure 5 shows the degree of bubble formation after taking the supernatant from the culture medium of the albumin-producing strain transformed with the albumin expression vector and the culture medium of the control strain. The supernatant of the culture medium ofS. cerevisiaeCEN.PK2-1C /pESC-URA-ALB, an albumin-producing strain shown on the right, showed the characteristics of egg white and More similar bubbles were created.
<실시예 3> 알부민 발현 형질전환체 배양액 내 단백질 함량 확인<Example 3> Confirmation of protein content in albumin-expressing transformant culture medium
알부민 발현 벡터로 형질전환된 알부민 생산 균주와 대조군 균주를 배양한 배양액에서 단백질 생산 정도를 BSA(Bradford assay) 방법으로 측정하였다.The degree of protein production in the culture medium in which the albumin-producing strain transformed with the albumin expression vector and the control strain were cultured was measured by a Bradford assay (BSA) method.
도 6은 알부민 발현 벡터로 형질전환된 알부민 생산 균주와 대조군 균주를 배양한 배양액에서 생산된 단백질의 농도를 측정한 것이다. 알부민 생산 균주인S. cerevisiae CEN.PK2-1C/pESC-URA-ALB 및P. pastoris pPICZa A-ALB는 대조군인S. cerevisiae CEN.PK2-1C/pESC-URA 및P. pastoris pPICZa A에 비해 단백질 농도가 더 높은 것으로 나타났다.6 is a measurement of the concentration of protein produced in the culture medium in which the albumin-producing strain transformed with the albumin expression vector and the control strain were cultured. The albumin-producing strains,S. cerevisiae CEN.PK2-1C/pESC-URA-ALB andP. pastoris pPICZa A-ALB, showed higher protein levels than the controls,S. cerevisiae CEN.PK2-1C/pESC-URA andP. pastoris pPICZa A. concentration was found to be higher.
<<실시예Example4> 알부민4> albumin 발현 형질전환체 배양액과 난백 비교 및 알부민 발현 형질전환체 배양액을 이용한 식품 - Comparison of expression transformant culture medium and egg white and food using albumin-expressing transformant culture medium -머랭meringue 쿠키 제조 cookie maker
알부민 발현 벡터로 형질전환된 알부민 생산 균주와 대조군 균주를 배양한 배양액을 13500rpm에서 원심분리하여 균체와 배양 배지를 분리하였다. 균체를 제거한 후 배양 배지를 머랭 쿠키에 사용하였다. 머랭 쿠키의 제조 방법은 5g의 계란 흰자와 25g의 배양 배지를 넣어 핸드믹서를 이용하여 머랭을 만들었다. 머랭을 짤주머니에 넣고 적당한 양을 오븐팬에 짠 후 80℃에서 1시간 동안 구워주었다.The albumin-producing strain transformed with the albumin expression vector and the culture medium in which the control strain were cultured were centrifuged at 13500 rpm to separate the cells and the culture medium. After removing the cells, the culture medium was used for meringue cookies. In the method of manufacturing meringue cookies, 5 g of egg white and 25 g of a culture medium were put into meringue using a hand mixer. Put the meringue in a piping bag, squeeze an appropriate amount into an oven pan, and bake at 80 ° C for 1 hour.
도 7은 알부민 생산 균주 배양액과 계란 흰자의 버블 생성 정도를 비교한 것이다. 왼쪽에 나타낸 알부민 생산 균주인 S. cerevisiae CEN.PK2-1C/pESC-URA-ALB 배양 배지는 오른쪽에 나타낸 대조군 난백에 비하여 버블이 더 많이 생성되었다.Figure 7 compares the degree of bubble formation between the albumin-producing strain culture medium and egg white. The culture medium of S. cerevisiae CEN.PK2-1C/pESC-URA-ALB, an albumin-producing strain shown on the left, produced more bubbles than the control egg white shown on the right.
도 8은 계란 흰자, 알부민 생산 균주의 배양 배지, 대조군 생산 균주의 배양 배지를 이용하여 머랭을 만들고 완성도를 비교한 것이다. 왼쪽은 계란 흰자, 가운데는 알부민 생산 균주의 배양 배지, 오른쪽은 대조군 생산 균주 배양 배지의 상층액(생산된 알부민과 동일한 양)을 이용하여 머랭을 만든 것이다. 그 결과, 알부민 생산 균주 상층액은 머랭을 양호하게 형성하였으며, 계란 흰자로 만든 머랭과 유사한 형상이었다. 그러나, 대조군 생산 균주의 배양액의 상층액은 버블을 생성하고 유지하지 못하였다. 따라서, 알부민 생산 균주 상층액은 계란 흰자를 대체할 수 있음을 알 수 있다.8 is a comparison of the degree of completeness of meringues made using egg white, a culture medium of an albumin-producing strain, and a culture medium of a control-producing strain. On the left, meringue was made using egg white, the culture medium of the albumin-producing strain in the middle, and the supernatant (the same amount as the albumin produced) of the culture medium of the control-producing strain on the right. As a result, the supernatant of the albumin-producing strain formed meringue well, and had a shape similar to that of egg white meringue. However, the supernatant of the culture of the control production strain did not generate and maintain bubbles. Therefore, it can be seen that the supernatant of the albumin-producing strain can replace egg white.
도 9는 알부민 생산 균주의 배양 배지와 계란 흰자를 이용하여 머랭 쿠키를 만들고 완성도를 비교한 것이다. 왼쪽은 계란 흰자, 가운데는 알부민 생산 균주의 배양 배지, 오른쪽은 대조군 균주 배양액의 상층액을 이용하여 머랭 쿠키를 만든 것이다. 그 결과, 알부민 생산 균주의 배양 배지를 사용한 머랭 쿠키는 계란 흰자를 사용한 머랭 쿠키와 마찬가지로 모양이 유지되었다. 그러나, 대조군 균주 배양액을 이용한 경우에는 머랭 쿠키가 그 모양을 유지하지 못하였다.9 is a comparison of the perfection of meringue cookies made using the culture medium of the albumin-producing strain and egg whites. On the left, meringue cookies were made using egg white, the culture medium of the albumin-producing strain in the middle, and the supernatant of the culture medium of the control strain on the right. As a result, the shape of the meringue cookies using the culture medium of the albumin-producing strain was maintained similarly to the meringue cookies using egg whites. However, when the control strain culture medium was used, the meringue cookie did not maintain its shape.
즉, 상기 알부민 생산 균주 및 이의 배양액을 이용하는 경우, 머랭 쿠키 뿐만 아니라 마카롱, 머랭 치즈, 머랭 타르타르, 머랭 케이크 등 다양한 디저트류를 제조할 수 있다. 더불어, 상기 알부민 생산 균주로부터 유래된 알부민은 식물성으로 계란과 같은 동물성 재료가 들어가지 않은 디저트를 제조하는데 활용될 수 있다.That is, when using the albumin-producing strain and its culture medium, not only meringue cookies but also various desserts such as macaron, meringue cheese, meringue tartar, and meringue cake can be prepared. In addition, albumin derived from the albumin-producing strain can be used to prepare desserts that are vegetable and do not contain animal ingredients such as eggs.
이상으로 본 발명의 특정한 부분을 상세히 기술한 바, 당업계의 통상의 지식을 가진 자에게 있어서 이러한 구체적인 기술은 단지 바람직한 구현 예일 뿐이며, 이에 본 발명의 범위가 제한되는 것이 아닌 점은 명백하다. 따라서, 본 발명의 실질적인 범위는 첨부된 청구항과 그의 등가물에 의하여 정의된다고 할 것이다.Having described specific parts of the present invention in detail above, it is clear that these specific techniques are only preferred embodiments for those skilled in the art, and the scope of the present invention is not limited thereto. Accordingly, the substantial scope of the present invention will be defined by the appended claims and equivalents thereof.
본 발명의 범위는 후술하는 특허 청구범위에 의하여 나타내어지며, 특허청구 범위의 의미 및 범위 그리고 그 균등개념으로부터 도출되는 모든 변경 또는 변형된 형태가 본 발명의 범위에 포함되는 것으로 해석되어야 한다.The scope of the present invention is indicated by the claims to be described later, and all changes or modifications derived from the meaning and scope of the claims and equivalent concepts thereof should be construed as being included in the scope of the present invention.
<110> THE CATHOLIC UNIVERSITY OF KOREA INDUSTRY-ACADEMIC COOPERATION FOUNDATION<120> Vegetable albumin and method for preparing same<130> ADP-2021-0722<160> 30<170> KoPatentIn 3.0<210> 1<211> 158<212> PRT<213> Glycine max 2S Albumin<400> 1Met Thr Lys Phe Thr Ile Leu Leu Ile Ser Leu Leu Phe Cys Ile Ala 1 5 10 15 His Thr Cys Ser Ala Ser Lys Trp Gln His Gln Gln Asp Ser Cys Arg 20 25 30 Lys Gln Leu Gln Gly Val Asn Leu Thr Pro Cys Glu Lys His Ile Met 35 40 45 Glu Lys Ile Gln Gly Arg Gly Asp Asp Asp Asp Asp Asp Asp Asp Asp 50 55 60 Asn His Ile Leu Arg Thr Met Arg Gly Arg Ile Asn Tyr Ile Arg Arg 65 70 75 80 Asn Glu Gly Lys Asp Glu Asp Glu Glu Glu Glu Gly His Met Gln Lys 85 90 95 Cys Cys Thr Glu Met Ser Glu Leu Arg Ser Pro Lys Cys Gln Cys Lys 100 105 110 Ala Leu Gln Lys Ile Met Glu Asn Gln Ser Glu Glu Leu Glu Glu Lys 115 120 125 Gln Lys Lys Lys Met Glu Lys Glu Leu Ile Asn Leu Ala Thr Met Cys 130 135 140 Arg Phe Gly Pro Met Ile Gln Cys Asp Leu Ser Ser Asp Asp145 150 155 <210> 2<211> 119<212> PRT<213> soybean Glycine max Albumin-1<400> 2Met Ala Val Phe Leu Leu Ala Thr Ser Thr Ile Met Phe Pro Thr Lys 1 5 10 15 Ile Glu Ala Ala Asp Cys Asn Gly Ala Cys Ser Pro Phe Glu Val Pro 20 25 30 Pro Cys Arg Ser Arg Asp Cys Arg Cys Val Pro Ile Gly Leu Phe Val 35 40 45 Gly Phe Cys Ile His Pro Thr Gly Leu Ser Ser Val Ala Lys Met Ile 50 55 60 Asp Glu His Pro Asn Leu Cys Gln Ser Asp Asp Glu Cys Met Lys Lys 65 70 75 80 Gly Ser Gly Asn Phe Cys Ala Arg Tyr Pro Asn Asn Tyr Ile Asp Tyr 85 90 95 Gly Trp Cys Phe Asp Ser Asp Ser Glu Ala Leu Lys Gly Phe Leu Ala 100 105 110 Met Pro Arg Ala Thr Thr Lys 115 <210> 3<211> 147<212> PRT<213> Cicer arietinum S2 Albumin<400> 3Met Ala Lys His Ile Phe Leu Val Thr Phe Phe Val Ala Leu Ile Leu 1 5 10 15 Phe Ile Ala His Thr Asn Ala Ser Lys Asp Glu Lys Glu Glu Ile Pro 20 25 30 Glu Ser Cys His Lys Gln Leu Lys Ser Leu Asn Leu Lys His Cys Glu 35 40 45 Lys Phe Leu Met Lys Arg Met Gln Lys Asp Glu Asp Glu Asp Asp Asp 50 55 60 Asn Val Ile Lys Met Arg Gly Val Asn Tyr Ile Arg Asn Arg Glu Glu 65 70 75 80 Gly Leu Lys Glu Asn Cys Cys Ala Gln Leu Ser Glu Val Asn Phe Leu 85 90 95 Asp Cys Arg Cys Glu Ala Leu Gln Lys Ile Gly Asp Asn Leu Ser Asp 100 105 110 Lys Cys Asp Lys Lys Glu Met Glu Glu Met Glu Arg Glu Leu Lys Ile 115 120 125 Leu Pro Leu Arg Cys Gly Ile Thr Pro Pro Leu Gly Cys Asp Leu Ser 130 135 140 Phe Asp Asn145 <210> 4<211> 138<212> PRT<213> chickpea Cicer arietinum Albumin-1<400> 4Met Ala Tyr Val Lys Leu Pro Pro Leu Thr Leu Phe Leu Leu Ala Thr 1 5 10 15 Phe Leu Ile Thr Phe Ser Thr Lys Lys Val Gly Ala Thr Cys Thr Gly 20 25 30 Val Cys Ser Phe Tyr Asp Ser Asn Pro Cys Gly Gly Asn Tyr Cys Phe 35 40 45 Cys His Phe Leu Asp Val Gly Asp Tyr Lys Gly Ile Cys Ile Asp Arg 50 55 60 Ser Phe Phe Ile Lys Thr Val Asp Glu Asp Pro Asn Leu Cys Gln Thr 65 70 75 80 His Ala Glu Cys Thr Lys Lys Gly Ser Gly Asn Phe Cys Gly Arg Tyr 85 90 95 Pro Asn Pro Asn Ile Lys Tyr Gly Arg Cys Phe Ala Ser Asn Thr Glu 100 105 110 Ala Glu Glu Phe Ser Asn Lys Phe Ser Tyr Tyr Ser Ser Arg Phe Ile 115 120 125 Lys Asp Phe Leu Asn Met Pro Val Val Ala 130 135 <210> 5<211> 222<212> PRT<213> chickpea Cicer arietinum Albumin-1<400> 5Met Ser Asn Leu Ser Ile Asp Ala Ala Tyr Arg Ser Ser Val His Asn 1 5 10 15 Glu Cys Tyr Ile Phe Val Lys Glu Arg Tyr Val Val Val Asn Tyr Asn 20 25 30 Pro Gly Gly Lys Lys Glu Lys Ile Ile His Gly Pro Lys His Ile Ser 35 40 45 Asp Gly Phe Pro Met Leu Ile Gly Thr Glu Phe Glu Lys Gly Ile Asp 50 55 60 Cys Ala Phe Asp Gly Asp Asn Asn Glu Ala Tyr Ile Phe Ser Gly Lys 65 70 75 80 Tyr Gly Gly Lys Ile Asp Tyr Val Asn Leu Thr Leu Leu Lys Asp Lys 85 90 95 Thr Pro Ile Lys Asp Met Phe Pro Ser Leu Lys Asp Thr Lys Leu Val 100 105 110 Asn Gly Ile Asp Ala Gly Ile Arg Ser Thr Gly Lys Asp Val Phe Leu 115 120 125 Phe Lys Gly Asp Glu Tyr Val Arg Ile Asp Tyr Gln Ser Glu Leu Val 130 135 140 Lys Ser Asn Lys Tyr Ile Arg Thr Gly Phe Gln Ser Leu Val Gly Thr145 150 155 160 Val Phe Glu Phe Gly Ile Asp Ala Ala Phe Ala Ser His Val Gln Asn 165 170 175 Glu Ala Tyr Ile Phe Lys Gly Asp Tyr Tyr Ala Arg Ile Asn Val Ala 180 185 190 Pro Gly Thr Ala Ser Gly Asp Phe Ile Val Gly Gly Arg Ile Lys Arg 195 200 205 Ile His Asp Asp Trp Pro Ala Leu His Ser Ile Leu Lys Asn 210 215 220 <210> 6<211> 143<212> PRT<213> Vigna radiata S2 Albumin<400> 6Met Ser Thr Ser Thr Ile Leu Ile Val Ala Leu Val Phe Val Gly His 1 5 10 15 Thr Cys Cys Ala Phe Lys Gly Thr Gln Glu Arg Leu Asn Cys Leu Glu 20 25 30 Gln Ile Lys Lys Ala Glu Leu Glu Tyr Cys Glu Asn Tyr Leu Met Thr 35 40 45 Lys Ile Gln Asp His His Asp Asp Val Ile Arg Ser Val Arg Met Asn 50 55 60 Asp Gly Phe Ser Glu Ala Lys Glu Leu His Glu Met Leu Arg Cys Cys 65 70 75 80 Gln Glu Val Arg Gly Met Ser Asn Pro Lys Cys Gln Cys Gln Ala Leu 85 90 95 Gln His Ile Met Glu Gly Gln Val Asp Lys Pro Lys Lys Glu Lys Leu 100 105 110 Gln Met Glu Glu Ala Leu Leu Asn Leu Phe Val Ser Cys Asn Phe Gly 115 120 125 Pro Met Glu Cys Asp Leu His Leu Asp Ser Glu Arg Glu Met Gln 130 135 140 <210> 7<211> 127<212> PRT<213> Mung bean Vigna radiata Albumin-1<400> 7Met Ala Tyr Val Arg Leu Ala Pro Leu Ala Leu Phe Leu Leu Ala Thr 1 5 10 15 Ser Thr Met Phe Pro Met Lys Lys Ile Glu Ala Val Asp Cys Ser Gly 20 25 30 Val Cys Ser Thr Phe Glu Arg Leu Pro Cys Arg Ser Leu Asp Cys Arg 35 40 45 Cys Ile Pro Ile Ala Leu Asp Phe Gly Leu Cys Phe Asn Arg Thr Gly 50 55 60 Leu Ser Ser Val Ala Lys Met Ile Asp Glu His Pro Asn Leu Cys Gln 65 70 75 80 Ser Asp Asp Glu Cys Met Lys Lys Gly Ser Gly Asn Phe Cys Ala Arg 85 90 95 Tyr Pro Asn Asn Tyr Ile Asp Tyr Gly Trp Cys Phe His Ser Asp Ser 100 105 110 Glu Ala Leu Lys Ala Phe Phe Ala Met Pro Thr Ala Ile Thr Met 115 120 125 <210> 8<211> 229<212> PRT<213> Mung bean Vigna radiata Albumin-2<400> 8Met Ser Asn Pro Pro Tyr Ile Asn Ala Ala Ile Arg Ser Ser Arg Asp 1 5 10 15 His Glu Val Tyr Phe Phe Ala Lys Asn Lys Tyr Val Arg Leu His Tyr 20 25 30 Thr Pro Gly Thr Tyr Asp Asp Lys Ile Leu Thr Asn Leu Arg Leu Ile 35 40 45 Ser Gly Ala Phe Pro Lys Leu Ala Gly Thr Pro Phe Ala Asp Pro Gly 50 55 60 Met Asp Cys Ala Phe Asp Thr Glu Ala Thr Leu Ala Tyr Val Phe Ser 65 70 75 80 Gly Asn Lys Cys Ala Tyr Ile Asp Tyr Ala Pro Gly Thr Thr Asn Asp 85 90 95 Lys Ile Leu Ala Gly Pro Thr Thr Ile Ala Gln Met Phe Pro Val Leu 100 105 110 Arg Asn Thr Val Phe Ala Glu Gly Ile Asp Ser Ala Phe Arg Ser Thr 115 120 125 Lys Gly Lys Glu Val Tyr Leu Phe Lys Gly Asn Lys Tyr Val Arg Ile 130 135 140 Ala Tyr Asp Ser Lys Gln Leu Val Gly Ser Ile Arg Asn Ile Ala Asp145 150 155 160 Gly Phe Pro Ile Leu Asn Gly Thr Ile Phe Glu Ser Gly Ile Asp Ala 165 170 175 Cys Phe Ala Ser His Lys Asp Ser Glu Ala Tyr Leu Phe Lys Gly Asn 180 185 190 Lys Tyr Val Arg Ile His Phe Thr Pro Gly Lys Thr Asp Asp Thr Leu 195 200 205 Ile Gly Asp Val Arg Pro Ile Leu Asp Gly Trp Pro Val Leu Arg Gly 210 215 220 Ile Leu Pro Val Ser225 <210> 9<211> 477<212> DNA<213> Glycine max 2S Albumin<400> 9atgaccaagt tcacaatcct cctcatctct cttctcttct gcatcgccca cacttgcagc 60gcctccaaat ggcagcacca gcaagatagc tgccgcaagc agctccaggg ggtgaacctc 120acgccctgcg agaagcacat catggagaag atccaaggcc gcggcgatga cgatgatgat 180gatgacgacg acaatcacat tctcaggacc atgcggggaa gaatcaacta cataaggagg 240aacgaaggaa aagacgaaga cgaagaagaa gaaggacaca tgcagaagtg ctgcacagaa 300atgagcgagc tgagaagccc caaatgccag tgcaaagcgc tgcagaagat aatggagaac 360cagagcgagg aactggagga gaagcagaag aagaaaatgg agaaggagct cattaacttg 420gctactatgt gcaggtttgg acccatgatc cagtgcgact tgtcctccga tgactaa 477<210> 10<211> 360<212> DNA<213> soybean Glycine max Albumin-1<400> 10atggctgtct tcttgcttgc cacttccacc ataatgttcc caacgaagat agaagcagca 60gattgtaatg gtgcatgttc acctttcgag gtgccaccgt gccgctcacg tgattgtcgt 120tgtgtcccta taggactatt tgttggtttc tgcatacatc caactggact ttcatctgtt 180gcgaagatga tcgacgaaca tcccaactta tgtcaatctg atgatgaatg catgaagaaa 240ggaagtggca atttttgcgc tcgttaccct aataattata tcgattatgg atggtgtttt 300gactctgatt ctgaagcact gaaaggcttc ttggccatgc ctagggcaac caccaagtaa 360 360<210> 11<211> 444<212> DNA<213> Cicer arietinum S2 Albumin<400> 11atggccaaac acattttcct cgtaactttc tttgtagctt taattctctt cattgctcac 60accaacgcct caaaggacga aaaagaagaa attccagaaa gttgccacaa gcaactcaag 120agtttgaacc taaaacattg tgagaaattc ctcatgaaga ggatgcagaa ggacgaagac 180gaggacgacg ataatgttat aaaaatgagg ggagtcaact acattcgaaa ccgcgaagaa 240ggactaaagg agaactgttg tgcacaactt agtgaagtga atttcttgga ttgtaggtgt 300gaagctttgc aaaagatagg agataatttg agtgataagt gtgataagaa ggagatggaa 360gaaatggaaa gggagttaaa gattttgcct ttgaggtgtg gtattacacc acctcttggg 420tgtgacttga gctttgataa ctaa 444<210> 12<211> 417<212> DNA<213> chickpea Cicer arietinum Albumin-1<400> 12atggcttatg ttaagctccc tcctttgact ctcttcttgc ttgccacatt cttaattacg 60ttctcgacga agaaggttgg agcaacttgt acgggtgtgt gttctttcta tgatagtaat 120ccatgcggtg gtaactattg cttctgtcac tttcttgatg taggagatta taagggaata 180tgcattgatc gatcattttt cataaaaaca gtagatgaag atcctaactt atgtcaaact 240catgctgaat gtacaaagaa aggaagtgga aacttttgcg gtcgttatcc taatccaaat 300ataaaatacg gaaggtgttt tgcatctaac actgaggccg aagaattctc caacaagttt 360tcttattact cctctagatt cataaaagac ttcttgaata tgcctgtagt tgcttaa 417<210> 13<211> 669<212> DNA<213> chickpea Cicer arietinum Albumin-2<400> 13atgtcaaatc ttagcataga tgctgcatac cgttcatctg tgcacaatga atgttacata 60tttgtgaaag aaaggtatgt ggttgtgaat tataatcctg gaggcaagaa ggaaaagatt 120attcatgggc cgaagcatat ttccgatgga ttcccaatgc tcatcggaac tgaatttgaa 180aagggaatag attgtgcctt tgatggtgat aacaatgaag catacatttt ctctggaaaa 240tatggtggca aaatagacta tgttaacctc acattactta aagataaaac tccaattaag 300gatatgtttc ctagtctcaa ggatactaaa cttgtaaatg gaatagatgc tggaataagg 360tccaccggaa aagatgtttt cttattcaaa ggtgatgagt atgttcgtat agactatcaa 420tctgagcttg ttaagtctaa taagtatatt cgcactggtt ttcaaagttt ggttgggaca 480gtctttgaat ttggaattga tgctgctttt gcttctcatg ttcagaatga agcttacatt 540ttcaaaggag attactatgc acgtatcaat gttgccccag gcacagctag tggtgacttt 600attgttggtg gtagaattaa gaggatccat gatgattggc ctgctcttca ttctatactc 660aaaaactag 669<210> 14<211> 432<212> DNA<213> Vigna radiata S2 Albumin<400> 14atgagcacaa gcaccatcct catcgtggct cttgtctttg tagggcatac atgttgcgcc 60ttcaaaggga cgcaggagcg actgaactgt ctggagcaga tcaagaaggc ggaactcgag 120tactgtgaga actaccttat gacgaagatc caagatcacc atgatgatgt tataaggagc 180gtgagaatga acgacggctt cagcgaggcg aaagaattac atgagatgct aaggtgctgc 240caggaagtga ggggtatgag caaccccaaa tgccagtgcc aagcgttgca gcatataatg 300gagggtcaag tagacaaacc gaagaaggag aagctgcaga tggaggaggc gcttctgaac 360ttgttcgtga gttgcaactt tggacccatg gaatgcgact tgcatttgga ctctgaaaga 420gaaatgcaat ag 432<210> 15<211> 384<212> DNA<213> Mung bean Vigna radiata Albumin-1<400> 15atggcttatg ttaggcttgc tcctttggct ctcttcttgc ttgccacttc cacaatgttt 60ccgatgaaga agatagaagc agtagactgt tcaggtgttt gttcaacgtt tgagaggcta 120ccatgcaggt cacttgattg tcgctgtatc cctattgcac tagatttcgg tttatgcttt 180aatcgaactg gactttcatc tgtggcgaag atgatagacg aacacccgaa cttatgtcaa 240tctgatgatg aatgcatgaa gaaaggaagt ggcaacttct gtgctcgtta tcccaataac 300tacatcgatt atggttggtg ttttcactct gattctgaag cacttaaagc tttcttcgcc 360atgcctacag caatcaccat gtga 384<210> 16<211> 690<212> DNA<213> Mung bean Vigna radiata Albumin-2<400> 16atgtcaaacc ctccttacat caatgctgca attcgttcat caagagatca tgaagtgtat 60ttcttcgcca agaacaagta tgtgcggttg cattacactc ccggaacata tgatgacaag 120attttaacta atctccgttt gattagtggt gcttttccaa aacttgcagg aacgccattt 180gcagaccctg gaatggactg tgcctttgac actgaagcga ctctagcata cgtgttctcc 240ggcaacaagt gtgcctacat agactatgct ccaggtacaa caaatgacaa gatactcgca 300ggtcctacca ctattgctca aatgtttcct gtcctcagaa acacggtgtt tgcggagggc 360atagactctg catttagatc aaccaaagga aaagaagttt acttattcaa gggcaataag 420tatgttcgca tagcctatga ttcgaaacag cttgttggca gcattcgcaa catcgctgat 480gggtttccta ttctgaatgg taccatcttt gaaagtggaa tcgatgcatg ttttgcttct 540cataaggact ctgaagctta ccttttcaaa ggaaacaagt atgtgcgtat tcatttcacc 600ccaggtaaaa ctgatgacac tcttatcggt gatgtcaggc ctatccttga tggttggccc 660gttcttagag gcattttgcc tgttagctaa 690<210> 17<211> 477<212> DNA<213> Artificial Sequence<220><223> Glycine max 2S Albumin<400> 17atgaccaagt tcactatatt attgatatct ctactgtttt gtattgctca cacatgttca 60gcgagtaaat ggcagcatca acaggacagt tgtaggaaac agctacaagg ggtaaattta 120acaccttgcg agaaacatat tatggaaaaa atccaaggga ggggcgatga tgacgacgac 180gatgacgatg acaatcacat attacgtact atgagagggc gtatcaatta catccgtagg 240aatgaaggca aggacgagga cgaggaagaa gagggtcaca tgcaaaagtg ttgcaccgaa 300atgagtgagt tgagaagccc caagtgccaa tgtaaggcgc tacagaagat tatggaaaat 360caaagcgaag agttggaaga aaaacagaag aaaaagatgg agaaggaact tataaacctg 420gctaccatgt gtcgttttgg accaatgatt cagtgcgact tgtctagtga cgattaa 477<210> 18<211> 360<212> DNA<213> Artificial Sequence<220><223> soybean Glycine max Albumin-1<400> 18atggcagtat tcctactggc gacatccact attatgtttc cgacaaaaat agaggccgct 60gattgcaatg gcgcatgtag cccgttcgaa gtacctccat gtagatccag ggactgtcgt 120tgcgtaccca taggactgtt cgttgggttc tgcatacatc ccactggtct gtcttccgtc 180gcgaaaatga ttgacgagca tccaaacttg tgtcagagtg atgatgagtg tatgaaaaag 240ggaagtggga atttttgtgc aaggtatcca aataattata tcgactacgg ttggtgtttc 300gatagtgata gcgaggcgct gaaaggtttt ttggcaatgc cgcgtgctac tactaagtaa 360 360<210> 19<211> 444<212> DNA<213> Artificial Sequence<220><223> Cicer arietinum S2 Albumin<400> 19atggcaaagc acatttttct tgtaacgttc tttgtggcgt tgattttatt catcgctcat 60actaatgctt ctaaagatga aaaagaggag ataccagaga gttgccataa acaattgaaa 120tcactaaact taaaacattg tgagaaattc ctaatgaagc gtatgcaaaa agacgaagat 180gaggatgatg acaacgttat taaaatgcgt ggggtcaact acatccgtaa tcgtgaggaa 240gggttaaaag agaattgctg tgctcaacta agcgaggtga atttcctgga ttgcaggtgt 300gaagctcttc aaaaaatcgg ggataacctt tctgacaagt gtgataaaaa agaaatggag 360gagatggaac gtgagttgaa gatcctgccg ttaagatgtg ggattacccc gccgctagga 420tgtgacttat cctttgataa ttaa 444<210> 20<211> 417<212> DNA<213> Artificial Sequence<220><223> chickpea Cicer arietinum Albumin-1<400> 20atggcctacg ttaaacttcc gccgttaaca ttattcttgc tggctacttt tttaatcaca 60ttttctacaa agaaggtcgg agcgacctgc acaggcgttt gctctttcta tgactccaat 120ccttgtgggg gcaattattg tttttgtcat tttttggacg ttggcgacta taagggtatt 180tgtattgata ggtctttctt cataaagaca gttgacgagg acccgaactt atgccagacc 240catgcagaat gtacgaaaaa gggttctgga aacttttgcg gacgttatcc gaaccctaac 300ataaaatatg gtagatgttt tgcttctaac accgaagcgg aggagttcag taacaaattc 360agttactatt ccagtaggtt tataaaggac ttccttaata tgccggttgt tgcataa 417<210> 21<211> 669<212> DNA<213> Artificial Sequence<220><223> chickpea Cicer arietinum Albumin-2<400> 21atgtcaaatc tgtcaataga tgccgcgtat agaagttcag tgcacaatga atgctatata 60ttcgtcaaag agagatatgt cgttgtaaac tataacccag gtggcaagaa agaaaagatt 120attcacggtc cgaaacatat atccgacgga ttccctatgt taattggtac tgaattcgaa 180aaaggtattg attgcgcctt cgatggtgac aacaatgaag catatatatt ttcagggaaa 240tatgggggta aaatagacta cgtgaatcta acactgctaa aggacaaaac acccattaaa 300gacatgtttc catccctgaa agacacgaag ctggtgaacg gcatcgatgc tggtatccgt 360agtacgggga aggacgtgtt ccttttcaaa ggggacgaat atgttcgtat agactatcag 420agtgaactgg taaagtccaa taaatacata agaacagggt ttcagagcct tgtaggcacc 480gtcttcgagt tcggcattga cgctgcattc gcgtctcacg tccaaaatga ggcatacatc 540ttcaaggggg attattacgc gcgtataaat gtcgcgcctg ggacagcttc cggtgacttt 600atcgttggcg ggaggattaa gaggattcat gatgattggc ccgctcttca cagtatattg 660aaaaactag 669<210> 22<211> 432<212> DNA<213> Artificial Sequence<220><223> Vigna radiata S2 Albumin<400> 22atgtcaactt ctaccatttt gatcgtggca ctggtttttg ttgggcacac ttgctgtgct 60ttcaaaggca cacaggagcg tcttaattgt ctggaacaaa tcaaaaaggc cgaattggaa 120tactgtgaga actatctgat gactaagatt caagaccacc acgacgacgt aataagaagc 180gtcaggatga acgatggctt ctcagaggct aaagagctac acgaaatgct tcgttgttgt 240caagaggtta gagggatgtc aaaccctaaa tgccagtgtc aagctctaca acatataatg 300gaggggcaag tcgacaaacc aaagaaggag aaactgcaaa tggaggaggc attactaaat 360ctatttgttt catgtaattt cggaccgatg gaatgtgatc ttcatttaga tagtgaaagg 420gaaatgcagt ag 432<210> 23<211> 384<212> DNA<213> Artificial Sequence<220><223> Mung bean Vigna radiata Albumin-1<400> 23atggcgtatg tacgtcttgc cccgctggcg ttgtttttac tagcaacctc tacaatgttc 60cctatgaaga aaattgaagc agtcgattgc tccggggtgt gttcaacctt tgagaggttg 120ccatgcagat ctctggactg caggtgcatc ccaatagcat tagattttgg gttgtgtttc 180aatagaaccg ggctatcatc agttgctaag atgattgacg agcaccctaa cctgtgtcaa 240tccgacgacg aatgcatgaa aaaggggtca gggaattttt gtgcgcgtta tccaaataac 300tacatagatt acggctggtg cttccatagc gatagcgaag ctctgaaggc attttttgcc 360atgcccacag cgatcactat gtga 384<210> 24<211> 690<212> DNA<213> Artificial Sequence<220><223> Mung bean Vigna radiata Albumin-2<400> 24atgtccaacc ccccctatat taacgctgca ataagaagta gcagagacca tgaggtgtat 60ttcttcgcta agaacaaata cgtgcgtctg cactacacgc ccgggacata tgatgataaa 120atcctaacaa atcttcgttt aatatccggt gcattcccaa aattagccgg aacgccgttt 180gcagatccgg gtatggattg tgcatttgac actgaggcga ccttagcata tgtattcagc 240ggtaataaat gcgcatacat cgactatgca ccaggaacca cgaacgacaa aattcttgca 300ggaccaacaa ccattgcgca gatgttcccg gttcttagaa acacggtctt tgcagagggg 360atagacagcg cgttccgtag cacgaagggc aaggaagttt acctattcaa gggcaacaag 420tacgtccgta tagcttatga tagcaagcaa ctagttggca gtatccgtaa tatcgcggat 480gggttcccca ttttgaacgg caccattttt gagtccggca tcgatgcttg cttcgcctcc 540cataaagact ccgaagccta cttattcaag gggaacaagt atgtgagaat ccactttact 600cccggcaaga cggacgacac ccttatcggc gacgtcagac caatccttga cggatggcct 660gtcttacgtg gaattttgcc ggtttcttaa 690<210> 25<211> 46<212> DNA<213> Artificial Sequence<220><223> pESC-URA-ALB insert F<400> 25tcccaacact cgaggcccga accaagttca ctatattatt gatatc 46<210> 26<211> 38<212> DNA<213> Artificial Sequence<220><223> pESC-URA-ALB insert R<400> 26tagtgatgat gatgatgatg atcgtcacta gacaagtc 38<210> 27<211> 28<212> DNA<213> Artificial Sequence<220><223> pPICZaA backbone F<400> 27gaacaaaaac tcatctcaga agaggatc 28<210> 28<211> 21<212> DNA<213> Artificial Sequence<220><223> pPICZaA backbone R<400> 28agcttcagcc tctcttttct c 21<210> 29<211> 46<212> DNA<213> Artificial Sequence<220><223> pPICZaA-ALB insert F<400> 29gaaaagagag gctgaagctg accaagttca ctatattatt gatatc 46<210> 30<211> 38<212> DNA<213> Artificial Sequence<220><223> pPICZaA-ALB insert R<400> 30tctgagatga gtttttgttc atcgtcacta gacaagtc 38 <110> THE CATHOLIC UNIVERSITY OF KOREA INDUSTRY-ACADEMIC COOPERATION FOUNDATION <120> Vegetable albumin and method for preparing same <130> ADP-2021-0722 <160> 30 <170> KoPatentIn 3.0 <210> 1 <211> 158 <212 > PRT <213> Glycine max 2S Albumin <400> 1 Met Thr Lys Phe Thr Ile Leu Leu Ile Ser Leu Leu Phe Cys Ile Ala 1 5 10 15 His Thr Cys Ser Ala Ser Lys Trp Gln His Gln Gln Asp Ser Cys Arg 20 25 30 Lys Gln Leu Gln Gly Val Asn Leu Thr Pro Cys Glu Lys His Ile Met 35 40 45 Glu Lys Ile Gln Gly Arg Gly Asp Asp Asp Asp Asp Asp Asp Asp Asp Asp 50 55 60 Asn His Ile Leu Arg Thr Met Arg Gly Arg Ile Asn Tyr Ile Arg Arg 65 70 75 80 Asn Glu Gly Lys Asp Glu Asp Glu Glu Glu Glu Gly His Met Gln Lys 85 90 95 Cys Cys Thr Glu Met Ser Glu Leu Arg Ser Pro Lys Cys Gln Cys Lys 100 105 110 Ala Leu Gln Lys Ile Met Glu Asn Gln Ser Glu Glu Leu Glu Glu Lys 115 120 125 Gln Lys Lys Lys Met Glu Lys Glu Leu Ile Asn Leu Ala Thr Met Cys 130 135 140 Arg Phe Gly Pro Met Ile Gln Cys Asp Leu Ser Ser Asp Asp 145 150 155 <210> 2 <211> 119 <212> PRT <213> soybean Glycine max Albumin-1 <400> 2 Met Ala Val Phe Leu Leu Ala Thr Ser Thr Ile Met Phe Pro Thr Lys 1 5 10 15 Ile Glu Ala Ala Asp Cys Asn Gly Ala Cys Ser Pro Phe Glu Val Pro 20 25 30 Pro Cys Arg Ser Arg Asp Cys Arg Cys Val Pro Ile Gly Leu Phe Val 35 40 45 Gly Phe Cys Ile His Pro Thr Gly Leu Ser Ser Val Ala Lys Met Ile 50 55 60 Asp Glu His Pro Asn Leu Cys Gln Ser Asp Asp Glu Cys Met Lys Lys 65 70 75 80 Gly Ser Gly Asn Phe Cys Ala Arg Tyr Pro Asn Asn Tyr Ile Asp Tyr 85 90 95 Gly Trp Cys Phe Asp Ser Asp Ser Glu Ala Leu Lys Gly Phe Leu Ala 100 105 110 Met Pro Arg Ala Thr Thr Lys 115 <210> 3 <211> 147 <212> PRT <213> Cicer arietinum S2 Albumin <400> 3 Met Ala Lys His Ile Phe Leu Val Thr Phe Phe Val Ala Leu Ile Leu 1 5 10 15 Phe Ile Ala His Thr Asn Ala Ser Lys Asp Glu Lys Glu Glu Ile Pro 20 25 30 Glu Ser Cys His Lys Gln Leu Lys Ser Leu Asn Leu Lys His Cys Glu 35 40 45 Lys Phe Leu Met Lys Arg Met Gln Lys Asp Glu Asp Glu Asp Asp Asp Asp 50 55 60 Asn Val Ile Lys Met Arg Gly Val Asn Tyr Ile Arg Asn Arg Glu Glu 65 70 75 80 Gly Leu Lys Glu Asn Cys Cys Ala Gln Leu Ser Glu Val Asn Phe Leu 85 90 95 Asp Cys Arg Cys Glu Ala Leu Gln Lys Ile Gly Asp Asn Leu Ser Asp 100 105 110 Lys Cys Asp Lys Lys Glu Met Glu Glu Met Glu Arg Glu Leu Lys Ile 115 120 125 Leu Pro Leu Arg Cys Gly Ile Thr Pro Pro Leu Gly Cys Asp Leu Ser 130 135 140 Phe Asp Asn 145 <210> 4 <211> 138 <212> PRT <213> chickpea Cicer arietinum Albumin-1 <400> 4 Met Ala Tyr Val Lys Leu Pro Pro Leu Thr Leu Phe Leu Leu Ala Thr 1 5 10 15 Phe Leu Ile Thr Phe Ser Thr Lys Lys Val Gly Ala Thr Cys Thr Gly 20 25 30 Val Cys Ser Phe Tyr Asp Ser Asn Pro Cys Gly Gly Asn Tyr Cys Phe 35 40 45 Cys His Phe Leu Asp Val Gly Asp Tyr Lys Gly Ile Cys Ile Asp Arg 50 55 60 Ser Phe Phe Ile Lys Thr Val Asp Glu Asp Pro Asn Leu Cys Gln Thr 65 70 75 80 His Ala Glu Cys Thr Lys Lys Gly Ser Gly Asn Phe Cys Gly Arg Tyr 85 90 95 Pro Asn Pro Asn Ile Lys Tyr Gly Arg Cys Phe Ala Ser Asn Thr Glu 100 105 110 Ala Glu Glu Phe Ser Asn Lys Phe Ser Tyr Tyr Ser Ser Arg Phe Ile 115 120 125 Lys Asp Phe Leu Asn Met Pro Val Val Ala 130 135 <210> 5 <211> 222 <212> PRT <213> chickpea Cicer arietinum Albumin-1 <400> 5 Met Ser Asn Leu Ser Ile Asp Ala Ala Tyr Arg Ser Ser Val His Asn 1 5 10 15 Glu Cys Tyr Ile Phe Val Lys Glu Arg Tyr Val Val Val Asn Tyr Asn 20 25 30 Pro Gly Gly Lys Lys Glu Lys Ile Ile His Gly Pro Lys His Ile Ser 35 40 45 Asp Gly Phe Pro Met Leu Ile Gly Thr Glu Phe Glu Lys Gly Ile Asp 50 55 60 Cys Ala Phe Asp Gly Asp Asn Asn Glu Ala Tyr Ile Phe Ser Gly Lys 65 70 75 80 Tyr Gly Gly Lys Ile Asp Tyr Val Asn Leu Thr Leu Leu Lys Asp Lys 85 90 95 Thr Pro Ile Lys Asp Met Phe Pro Ser Leu Lys Asp Thr Lys Leu Val 100 105 110 Asn Gly Ile Asp Ala Gly Ile Arg Ser Thr Gly Lys Asp Val Phe Leu 115 120 125 Phe Lys Gly Asp Glu Tyr Val Arg Ile Asp Tyr Gln Ser Glu Leu Val 130 135 140 Lys Ser Asn Lys Tyr Ile Arg Thr Gly Phe Gln Ser Leu Val Gly Thr 145 150 155 160 Val Phe Glu Phe Gly Ile Asp Ala Ala Phe Ala Ser His Val Gln Asn 165 170 175 Glu Ala Tyr Ile Phe Lys Gly Asp Tyr Ala Arg Ile Asn Val Ala 180 185 190 Pro Gly Thr Ala Ser Gly Asp Phe Ile Val Gly Gly Arg Ile Lys Arg 195 200 205 Ile His Asp Asp Trp Pro Ala Leu His Ser Ile Leu Lys Asn 210 215 220 <210> 6 <211> 143 <212> PRT <213> Vigna radiata S2 Albumin <400> 6 Met Ser Thr Ser Thr Ile Leu Ile Val Ala Leu Val Phe Val Gly His 1 5 10 15 Thr Cys Cys Ala Phe Lys Gly Thr Gln Glu Arg Leu Asn Cys Leu Glu 20 25 30 Gln Ile Lys Lys Ala Glu Leu Glu Tyr Cys Glu Asn Tyr Leu Met Thr 35 40 45 Lys Ile Gln Asp His His Asp Asp Val Ile Arg Ser Val Arg Met Asn 50 55 60 Asp Gly Phe Ser Glu Ala Lys Glu Leu His Glu Met Leu Arg Cys Cys 65 70 75 80 Gln Glu Val Arg Gly Met Ser Asn Pro Lys Cys Gln Cys Gln Ala Leu 85 90 95 Gln His Ile Met Glu Gly Gln Val Asp Lys Pro Lys Lys Glu Lys Leu 100 105 110 Gln Met Glu Ala Leu Leu Asn Leu Phe Val Ser Cys Asn Phe Gly 115 120 125 Pro Met Glu Cys Asp Leu His Leu Asp Ser Glu Arg Glu Met Gln 130 135 140 < 210> 7 <211> 127 <212> PRT <213> Mung bean Vigna radiata Albumin-1 <400> 7 Met Ala Tyr Val Arg Leu Ala Pro Leu Ala Leu Phe Leu Leu Ala Thr 1 5 10 15 Ser Thr Met Phe Pro Met Lys Lys Ile Glu Ala Val Asp Cys Ser Gly 20 25 30 Val Cys Ser Thr Phe Glu Arg Leu Pro Cys Arg Ser Leu Asp Cys Arg 35 40 45 Cys Ile Pro Ile Ala Leu Asp Phe Gly Leu Cys Phe Asn Arg Thr Gly 50 55 60 Leu Ser Ser Val Ala Lys Met Ile Asp Glu His Pro Asn Leu Cys Gln 65 70 75 80 Ser Asp Asp Glu Cys Met Lys Lys Gly Ser Gly Asn Phe Cys Ala Arg 85 90 95 Tyr Pro Asn Asn Tyr Ile Asp Tyr Gly Trp Cys Phe His Ser Asp Ser 100 105 110 Glu Ala Leu Lys Ala Phe Phe Ala Met Pro Thr Ala Ile Thr Met 115 120 125 <210> 8 <211> 229 <212> PRT <213> Mung bean Vigna radiata Albumin-2 <400> 8 Met Ser Asn Pro Pro Tyr Ile Asn Ala Ala Ile Arg Ser Ser Arg Asp 1 5 10 15 His Glu Val Tyr Phe Phe Ala Lys Asn Lys Tyr Val Arg Leu His Tyr 20 25 30 Thr Pro Gly Thr Tyr Asp Asp Lys Ile Leu Thr Asn Leu Arg Leu Ile 35 40 45 Ser Gly Ala Phe Pro Lys Leu Ala Gly Thr Pro Phe Ala Asp Pro Gly 50 55 60 Met Asp Cys Ala Phe Asp Thr Glu Ala Thr Leu Ala Tyr Val Phe Ser 65 70 75 80 Gly Asn Lys Cys Ala Tyr Ile Asp Tyr Ala Pro Gly Thr Thr Asn Asp 85 90 95 Lys Ile Leu Ala Gly Pro Thr Thr Ile Ala Gln Met Phe Pro Val Leu 100 105 110 Arg Asn Thr Val Phe Ala Glu Gly Ile Asp Ser Ala Phe Arg Ser Thr 115 120 125 Lys Gly Lys Glu Val Tyr Leu Phe Lys Gly Asn Lys Tyr Val Arg Ile 130 135 140 Ala Tyr Asp Ser Lys Gln Leu Val Gly Ser Ile Arg Asn Ile Ala Asp 145 150 155 160 Gly Phe Pro Ile Leu Asn Gly Thr Ile Phe Glu Ser Gly Ile Asp Ala 165 170 175 Cys Phe Ala Ser His Lys Asp Ser Glu Ala Tyr Leu Phe Lys Gly Asn 180 185 190 Lys Tyr Val Arg Ile His Phe Thr Pro Gly Lys Thr Asp Asp Thr Leu 195 200 205 Ile Gly Asp Val Arg Pro Ile Leu Asp Gly Trp Pro Val Leu Arg Gly 210 215 220 Ile Leu Pro Val Ser 225 <210> 9 <211> 477 <212> DNA <213> Glycine max 2S Albumin <400> 9 atgaccaagt tcacaatcct cctcatctct cttctcttct gcatcgccca cacttgcagc 60 gcctccaaat ggcagcacca gcaagatagc tgccgcaagc agctccaggg ggtgaacctc 120 acgccctgcg agaagcacat catggagaag atccaaggcc gcggcgatga cgatgatgat 180 gatgacgacg acaatcacat tctcaggacc atgcggggaa gaatcaacta cataaggagg 240 aacgaaggaa aagacgaaga cgaagaagaa gaaggacaca tgcagaagtg ctgcacagaa 300 atgagcgagc tgagaagccc caaatgccag tgcaaagcgc tgcagaagat aatggagaac 360 cagagcgagg aactggagga gaagcagaag aagaaaatgg agaaggagct cattaacttg 420 gctactatgt gcaggtttgg acccatgatc cagtgcgact tgtcctccga tgactaa 477 <210> 10 <211> 360 <21 2> DNA <213> soybean Glycine max Albumin-1 <400> 10 atggctgtct tcttgcttgc cacttccacc ataatgttcc caacgaagat agaagcagca 60 gattgtaatg gtgcatgttc acctttcgag gtgccaccgt gccgctcacg tgattgtcgt 120 tgtgtcccta taggact att tgttggtttc tgcatacatc caactggact ttcatctgtt 180 gcgaagatga tcgacgaaca tcccaactta tgtcaatctg atgatgaatg catgaagaaa 240 ggaagtggca attttgcgc tcgttaccct aataattata tcgattatgg atggtgtttt 300 gactctgatt ctgaagcact gaaaggcttc ttggccatgc ctagggcaac caccaagtaa 360 360 <210> 11 <211> 444 <212> DNA <213> Cicer arietinum S2 Albumin <400> 11 atggccaaac acattttcct cgtaactttc tttgtagctt taattctctt cattgctcac 60 accaacgcct caaaggacga aaaagaagaa attccagaaa gttgccacaa gcaactcaag 120 agtttgaacc taaaacattg tgagaaattc ctcatgaaga ggatgcagaa ggacgaagac 180 gaggacgacg ataatgttat aaaaatgagg ggaggtcaact acattcgaaa ccgcgaagaa 240 ggactaaagg agaactgttg tgcacaactt agtgaagtga atttcttgga ttgtaggtgt 300 gaagctttgc aaaagatagg agataatttg agtgataagt gtgataagaa ggagat ggaa 360 gaaatggaaa gggagttaaa gattttgcct ttgaggtgg gtattacacc acctcttggg 420 tgtgacttga gctttgataa ctaa 444 <210> 12 <211> 417 <212> DNA <213> chickpea Cicer arietinum Albumin-1 <400> 12 atggcttatg ttaagctccc tcctttgact ctcttcttgc ttgccacatt cttaattacg 60 ttctcgacga agaaggttgg agcaacttgt acgggtgtgt gttctttcta tgatagtaat 120 ccatgcggtg gtaactattg cttctgtcac tttct tgatg taggagatta taagggaata 180 tgcattgatc gatcattttt cataaaaaca gtagatgaag atcctaactt atgtcaaact 240 catgctgaat gtacaaagaa aggaagtgga aacttttgcg gtcgtttcc taatccaaat 300 ataaaatacg gaaggtgttt tgcatctaac actga ggccg aagaattctc caacaagttt 360 tcttattact cctctagatt cataaaagac ttcttgaata tgcctgtagt tgcttaa 417 <210> 13 <211> 669 <212> DNA <213> chickpea Cicer arietinum Albumin-2 <400> 13 atgtcaaatc ttagcataga tgctgcatac cgttcatctg tgcacaatga atgttacata 60 tttgtgaaag aaaggtatgt ggttgtgaat tataatcctg gaggcaagaa ggaaaagatt 120 attcatgggc cgaagcatat ttccgatgga ttcccaatgc tcatcggaac tgaatttgaa 180 aagggaatag attgtgcctt tgatggtgat aacaatgaag catacatttt ctctggaaaa 240 tatggtggca aaatagacta tgttaacctc acattactta aagataaaac tccaattaag 300 gatatgtttc ctagtctcaa ggatactaaa cttgtaaaatg gaatagatgc tggaataagg 360 tccaccggaa aagatgtttt cttattcaaa ggtgatgagt atgttcgtat agactatcaa 420 tctgagcttg ttaagtctaa taagtatatt cgcactggtt ttcaaagttt ggttgggaca 480 gtctttgaat ttggaatt ga tgctgctttt gcttctcatg ttcagaatga agcttacatt 540 ttcaaaggag attactatgc acgtatcaat gttgccccag gcacagctag tggtgacttt 600 attgttggtg gtagaattaa gaggatccat gatgattggc ctgctcttca ttctatactc 660 aaaaactag 669 <210> 14 <211> 432 <212> DNA <213> Vigna radiata S2 Albumin <400> 14 atgagcacaa gcaccatcct catcgtggct ctt gtctttg tagggcatac atgttgcgcc 60 ttcaaaggga cgcaggagcg actgaactgt ctggagcaga tcaagaaggc ggaactcgag 120 tactgtgaga actaccttat gacgaagatc caagatcacc atgatgatgt tataaggagc 180 gtgagaatga acgacggctt cagcgaggcg aaagaattac atgagatgct aaggtgctgc 240 caggaagtga ggggtatgag caaccccaaa tgccagtgcc aagcgttgca gcatataatg 300 gagggtcaag tagacaaacc gaagaag gag aagctgcaga tggaggaggc gcttctgaac 360 ttgttcgtga gttgcaactt tggacccatg gaatgcgact tgcatttgga ctctgaaaga 420 gaaatgcaat ag 432 <210> 15 <211> 384 <212> DNA <213> Mung bean Vigna radiata Albumin-1 <400> 15 atggcttatg ttaggcttgc tcctttggct ctcttcttgc ttgccacttc cacaatgttt 60 ccgatgaaga agatagaagc agtagactgt tcaggtgttt gttcaacgtt tgagaggcta 120 ccatgcaggt cacttgattg tcgctgtatc cctattgcac tagatttcgg tttatgcttt 180 aatcgaactg gactttcatc tgtggcgaag atgatagacg aacacccgaa cttatgtcaa 240 tctgatgatg aatgcatgaa gaaaggaagt ggcaacttct gtgctcgtta tcccaataac 300 tacatcgatt atggt tggtg ttttcactct gattctgaag cacttaaagc tttcttcgcc 360 atgcctacag caatcaccat gtga 384 <210> 16 <211> 690 <212> DNA <213> Mung bean Vigna radiata Albumin-2 <400> 16 atgtcaaacc ctccttacat caatgctgca attcgttcat caagagatca tgaagt gtat 60 ttcttcgcca agaacaagta tgtgcggttg cattacactc ccggaacata tgatgacaag 120 attttaacta atctccgttt gattagtggt gctttccaa aacttgcagg aacgccattt 180 gcagaccctg gaatggactg tgcctttgac actgaagcga ctctagcata cgtgttctcc 240 ggcaacaagt gtgcctacat agactatgct ccaggtacaa caaatgacaa gatactcgca 300 ggtcctacca ctattgctca aatgt ttcct gtcctcagaa acacggtgtt tgcggagggc 360 atagactctg catttagatc aaccaaagga aaagaagttt acttattcaa gggcaataag 420 tatgttcgca tagcctatga ttcgaaacag cttgttggca gcattcgcaa catcgctgat 480 gggtttccta ttctgaat gg taccatcttt gaaagtgggaa tcgatgcatg ttttgcttct 540 cataaggact ctgaagctta ccttttcaaa ggaaacaagt atgtgcgtat tcatttcacc 600 ccaggtaaaa ctgatgacac tcttatcggt gatgtcaggc ctatccttga tggttggccc 660 gttcttagag gcattttgcc tgttagctaa 690 <210> 17 <211> 477 <212> DNA <213> Artificial Sequence <2 20> <223> Glycine max 2S Albumin <400> 17 atgaccaagt tcactatatt attgatatct ctactgtttt gtattgctca cacatgttca 60 gcgagtaaat ggcagcatca acaggacagt tgtaggaaac agctacaagg ggtaaattta 120 acaccttgcg agaaacatat tatggaaaaa atccaaggga ggggcgatga tgacgacgac 180 gatgacgatg acaatcacat attacgtact atgagagggc gt a aaaagatgg agaaggaact tataaacctg 420 gctaccatgt gtcgttttgg accaatgatt cagtgcgact tgtctagtga cgattaa 477 <210> 18 <211> 360 <212> DNA <213> Artificial Sequence <220> <223> soybean Glycine max Albumin-1 <400> 18 atggcagtat tcctactggc gacatccact attatgtttc cgacaaaaat agaggccgct 60 gattgcaatg gcgcatgtagtag cccgt tcgaa gtacctccat gtagatccag ggactgtcgt 120 tgcgtaccca taggactgtt cgttgggttc tgcatacatc ccactggtct gtcttccgtc 180 gcgaaaatga ttgacgagca tccaaacttg tgtcagagtg atgatgagtg tatgaaaaag 240 ggaagtggga attttgtgc aaggtatcca aataattata tcgactacgg ttggtgtttc 300 gatagtgata gcgaggcgct gaaaggtttt ttggcaatgc cgcgtgctac tactaagtaa 360 360 <210> 19 <211> 444 <212> DNA <213> Artificial Sequence <220> <223> Cicer arietinum S2 Albumin <400> 19 atggcaaagc acatttttct tgtaacgttc tttgtggcgt tttttatt catcgctcat 60 actaatgctt ctaaagatga aaaagaggag ataccagaga gttgccataa acaattgaaa 120 tcactaaact taaaacattg tgagaaattc c taatgaagc gtatgcaaaa agacgaagat 180 gaggatgatg acaacgttat taaaatgcgt ggggtcaact acatccgtaa tcgtgaggaa 240 gggttaaaag agaattgctg tgctcaacta agcgaggtga attcctgga ttgcaggtgt 300 gaagctcttc aaaa aatcgg ggataacctt tctgacaagt gtgataaaaa agaaatggag 360 gagatggaac gtgagttgaa gatcctgccg ttaagatgg ggattacccc gccgctagga 420 tgtgacttat cctttgataa ttaa 444 <210> 20 <211> 417 <212> DNA <213> Artificial Sequence <220> <223> chickpea Cicer arietinum Albumin-1 <400> 20 atggcctacg ttaaacttcc gccgttaaca ttattcttgc tggctacttt tttaatcaca 60 ttttctacaa agaaggtcgg agcgacctgc acaggcgttt gctctttcta tgactccaat 120 ccttgtgggg gcaattattg ttttgtcat tttttggacg ttggcgacta taagggtatt 180 tgtattgata ggtctttctt cataaagaca gttgacgagg acc cgaactt atgccagacc 240 catgcagaat gtacgaaaaa gggttctgga aacttttgcg gacgttatcc gaaccctaac 300 ataaaatatg gtagatgttt tgcttctaac accgaagcgg aggagttcag taacaaattc 360 agttactatt ccagtaggtt tataaaggac ttccttaata tgccggttgt tgcataa 417 <210> 21 <211> 669 <212> DNA <213> Artificial Sequence <220> <223> chickpea Cicer arietinum Albumin-2 <400> 21 atgtcaaatc tgtcaataga tgccgcgtat agaagttcag tgcacaatga atgctatata 60 ttcgtcaaag agagatatgt cgttgtaaac tataacccag gtggcaaga a a agaaaagatt 120 attcacggtc cgaaacatat atccgacgga ttccctatgt taattggtac tgaattcgaa 180 aaaggtattg attgcgcctt cgatggtgac aacaatgaag catatatatt ttcagggaaa 240 tatgggggta aaatagacta cgtgaatcta acactgctaa aggacaaaac acccattaaa 300 gacatgtttc catccctgaa agacacgaag ctggtgaacg gcatcgatgc tggtatccgt 360 agtacgggga aggacgtgtt ccttttcaa a ggggacgaat atgttcgtat agactatcag 420 agtgaactgg taaagtccaa taaatacata agaacagggt ttcagagcct tgtaggcacc 480 gtcttcgagt tcggcattga cgctgcattc gcgtctcacg tccaaaatga ggcatacatc 540 ttcaaggggg attattacgc gc gtataaat gtcgcgcctg ggacagcttc cggtgacttt 600 atcgttggcg ggaggattaa gaggattcat gatgattggc ccgctcttca cagtatattg 660 aaaaactag 669 <210> 22 <211> 432 <212> DNA <213> Artificial Sequence <220> <223> Vigna radiata S2 Albumin <400> 22 atgtcaactt ctaccatttt g atcgtggca ctggtttttg ttgggcacac ttgctgtgct 60 ttcaaaggca cacaggagcg tcttaattgt ctggaacaaa tcaaaaaggc cgaattggaa 120 tactgtgaga actatctgat gactaagatt caagaccacc acgacgacgt aataagaagc 180 gtcaggatga acgatggctt ctcagaggct aaagagctac acgaaatgct tcgttgttgt 240 caagaggtta gagggatgtc aaaccctaa a tgccagtgtc aagctctaca acatataatg 300 gaggggcaag tcgacaaacc aaagaaggag aaactgcaaa tggaggaggc attactaaat 360 ctatttgttt catgtaattt cggaccgatg gaatgtgatc ttcatttaga tagtgaaagg 420 gaaatgcagt ag 432 < 210> 23 <211> 384 <212> DNA <213> Artificial Sequence <220> <223> Mung bean Vigna radiata Albumin-1 <400> 23 atggcgtatg tacgtcttgc cccgctggcg ttgtttttac tagcaacctc tacaatgttc 60 cctatgaaga aaattgaagc agtcgattgc tccggggtgt gttcaacctt t gagaggttg 120 ccatgcagat ctctggactg caggtgcatc ccaatagcat tagattttgg gttgtgtttc 180 aatagaaccg ggctatcatc agttgctaag atgattgacg agcaccctaa cctgtgtcaa 240 tccgacgacg aatgcatgaa aaaggggtca gggaattttt gtgcgcgtta tccaaataac 300 tacatagatt acggctggtg cttccatagc gatagcgaag ctctgaaggc attttttgcc 360 atgccacag cgatcact at gtga 384 <210> 24 <211> 690 <212> DNA <213> Artificial Sequence <220> <223> Mung bean Vigna radiata Albumin -2 <400> 24 atgtccaacc ccccctatat taacgctgca ataagaagta gcagagacca tgaggtgtat 60 ttcttcgcta agaacaaata cgtgcgtctg cactacacgc ccgggacata tgatgataaa 120 atcctaacaa atcttcgttt aatatccggt gcattcccaa aattagccgg aacgccgttt 180 gcagatccgg gtatggattg tgcatttgac actgaggcga ccttagcata tgtattcagc 240 ggtaataaat gcgcatacat cgactatgca ccaggaacca cgaacgacaa aattcttgca 300 ggaccaacaa ccattgcgca gatgttcccg gttcttagaa acacggtctt tgcagagggg 360 atagacagcg cgttccgtag cacgaagggc aaggaagttt acctattcaa gggcaacaag 420 tacgtccgta tagcttatga tagcaagcaa ctagttggca gtatccgtaa tatcgcggat 480 gggttcccca ttttgaacgg caccattttt gagtccggca tcgatgcttg cttcgcctcc 540 cataaagact dna 213> Artificial Sequence <220> <223> pESC-URA-ALB insert F <400> 25 tcccaacact cgaggcccga accaagttca ctatattatt gatatc 46 <210> 26 <211> 38 <212> DNA <213> Artificial Sequence <220> <223> pESC-URA-ALB insert R <400> 26 tagtgatgat gatgatgatg atcgtcacta gacaagtc 38 <210> 27 <211> 28 <212> DNA <213> Artificial Sequence <220> <223> pPICZaA backbone F <400> 27 gaacaaaaac tcatctcaga agaggatc 28 <210> 28 <211> 21 <212> DNA <213> Artificial Sequence <220> <223> pPICZaA backbone R <400> 28 agcttcagcc tctcttttct c 21 <210> 29 <211> 46 <212> DNA <213> Artificial Sequence <220> <223> pPICZaA-ALB insert F <400> 29 gaaaagagag gctgaagctg accaagttca ctatattatt gatatc 46 <210> 30 <211> 38 <212> DNA <213> Artificial Sequence <220> <223> pPICZaA-ALB insert R <400> 30 tctgagatga gtttttgttc atcgtcacta gacaagtc 38
Claims (11)
Translated fromKoreanPriority Applications (1)
| Application Number | Priority Date | Filing Date | Title |
|---|---|---|---|
| KR1020210193031AKR20230102695A (en) | 2021-12-30 | 2021-12-30 | Vegetable albumin and method for preparing same |
Applications Claiming Priority (1)
| Application Number | Priority Date | Filing Date | Title |
|---|---|---|---|
| KR1020210193031AKR20230102695A (en) | 2021-12-30 | 2021-12-30 | Vegetable albumin and method for preparing same |
Publications (1)
| Publication Number | Publication Date |
|---|---|
| KR20230102695Atrue KR20230102695A (en) | 2023-07-07 |
Family
ID=87153871
Family Applications (1)
| Application Number | Title | Priority Date | Filing Date |
|---|---|---|---|
| KR1020210193031ACeasedKR20230102695A (en) | 2021-12-30 | 2021-12-30 | Vegetable albumin and method for preparing same |
Country Status (1)
| Country | Link |
|---|---|
| KR (1) | KR20230102695A (en) |
- 2021
- 2021-12-30KRKR1020210193031Apatent/KR20230102695A/ennot_activeCeased
Similar Documents
| Publication | Publication Date | Title |
|---|---|---|
| JP6793957B2 (en) | Production of non-caloric sweeteners using modified whole cell catalysts | |
| US6309868B1 (en) | Cloning of the prolyl-dipeptidyl-peptidase from Aspergillus oryzae | |
| US20060183675A1 (en) | Antimicrobial polypeptide from aspergillus niger | |
| JP2000507102A (en) | Polypeptide having phytase activity and nucleic acid encoding the same | |
| TW201000634A (en) | Proline-specific protease | |
| CN102660614A (en) | Method for making mature insulin polypeptides | |
| KR20190069014A (en) | An activity-improved xylanase mutant and a method for producing the same | |
| US20250145675A1 (en) | Production of natural peptide sweetener | |
| TW201018401A (en) | Polypeptides having antimicrobial activity | |
| US9273320B2 (en) | Method of producing a sweet protein | |
| EP1235488A1 (en) | Product and method for control of obesity | |
| KR20230023376A (en) | Recombinant yeast introduced with a gene encoding retinol dehydrogenase and manufacturing method the same | |
| JPH06500022A (en) | Cloning and expression of DNA molecules encoding fungal-derived arabinan-degrading enzymes | |
| EP1512747B1 (en) | Gene encoding glutathione synthetase from Candida utilis | |
| KR20120122990A (en) | Glycoside hydrolase From lactic acid bacteria And Use Thereof | |
| JP2905230B2 (en) | Method for producing human lysozyme | |
| KR20230102695A (en) | Vegetable albumin and method for preparing same | |
| AU753666B2 (en) | Enhanced expression of proteolytic enzymes in koji mold | |
| US20230340077A1 (en) | Production of myoglobin from trichoderma using a feeding media | |
| US7553640B2 (en) | Saponin-decomposing enzyme, gene thereof and large-scale production system for producing soyasapogenol B | |
| KR102016056B1 (en) | Method for producing bisabolol using transformed yeast | |
| KR102513450B1 (en) | Novel ectoine synthase and uses thereof | |
| KR102113588B1 (en) | Mass Production System of Oligopeptide with His-Pro Repeats | |
| KR20190006390A (en) | A strain producing high level of fusaricidin with improved safety and the method for preparing the strain | |
| Lai et al. | Production of Food Additives and Food Processing Enzymes |
Legal Events
| Date | Code | Title | Description |
|---|---|---|---|
| PA0109 | Patent application | St.27 status event code:A-0-1-A10-A12-nap-PA0109 | |
| PA0201 | Request for examination | St.27 status event code:A-1-2-D10-D11-exm-PA0201 | |
| D13-X000 | Search requested | St.27 status event code:A-1-2-D10-D13-srh-X000 | |
| D14-X000 | Search report completed | St.27 status event code:A-1-2-D10-D14-srh-X000 | |
| PG1501 | Laying open of application | St.27 status event code:A-1-1-Q10-Q12-nap-PG1501 | |
| E902 | Notification of reason for refusal | ||
| PE0902 | Notice of grounds for rejection | St.27 status event code:A-1-2-D10-D21-exm-PE0902 | |
| T11-X000 | Administrative time limit extension requested | St.27 status event code:U-3-3-T10-T11-oth-X000 | |
| P11-X000 | Amendment of application requested | St.27 status event code:A-2-2-P10-P11-nap-X000 | |
| P13-X000 | Application amended | St.27 status event code:A-2-2-P10-P13-nap-X000 | |
| E601 | Decision to refuse application | ||
| PE0601 | Decision on rejection of patent | St.27 status event code:N-2-6-B10-B15-exm-PE0601 | |
| T11-X000 | Administrative time limit extension requested | St.27 status event code:U-3-3-T10-T11-oth-X000 | |
| T13-X000 | Administrative time limit extension granted | St.27 status event code:U-3-3-T10-T13-oth-X000 | |
| E13-X000 | Pre-grant limitation requested | St.27 status event code:A-2-3-E10-E13-lim-X000 | |
| P11-X000 | Amendment of application requested | St.27 status event code:A-2-2-P10-P11-nap-X000 |